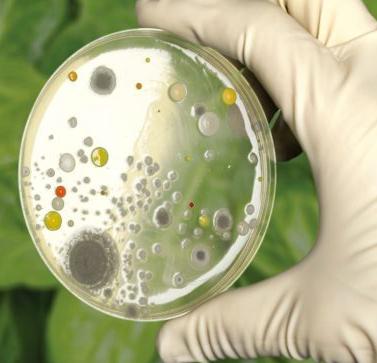
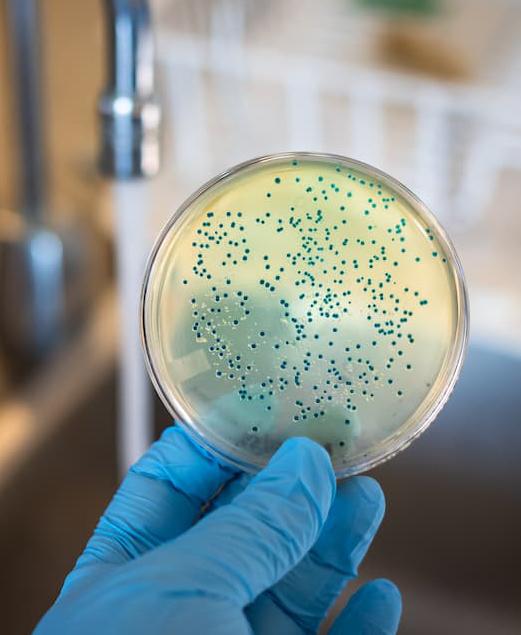
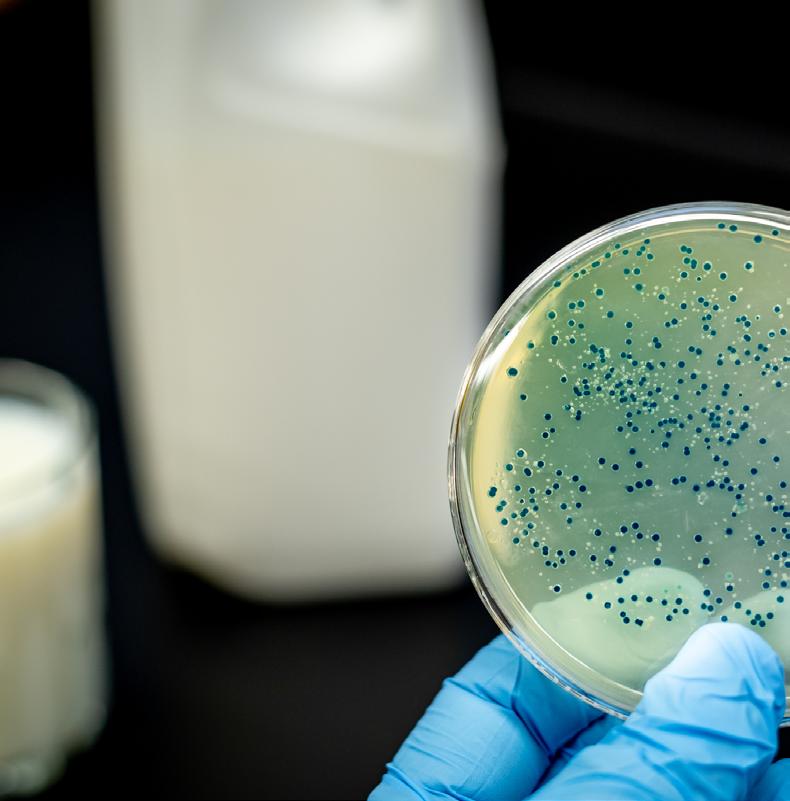

Food Safety
SCIENCE & RESEARCH:
CRONOBACTER IN AFRICA
DR. ROY MUGIIRA

NATIONAL BIOSAFETY AUTHORITY
We are ready to regulate GM foods in Kenya
SA’S LABELING REGULATIONS
REGULATORY: FORMULATION:

SALT
INDUSTRY FOCUS:
WATER RE-USE IN DAIRY INDUSTRY
SCIENCE & RESEARCH:
AOAC AFRICA DEBUTS PLATFORM

WWW.FOODSAFETYAFRICA.NET YEAR 3 | ISSUE NO. 1 MARCH 2023

Meet & Network with the leading manufacturers and distributors of ingredients technologies from across the World at the Food Ingredients Africa Expo. Discover the latest market trends for your next new products innovation project. WWW.AFMASS.COM A SPECIAL PAVILLION AT: WWW.AFMASS.COM Food Colours & Flavours • Enzymes and Flour Improvers • Sugar, Fat & Salt Replacers • Emulsifiers & Antioxidants • Vitamins, Minerals & Supplements • Thickeners, Stabilisers, Humectants & Gums • Specialty Starches, Proteins & Oils • Sweeteners & Acidulants • Herbs & Spices • Antioxidants & Preservatives • Flavour Enhancers • PLUS MANY MORE . . . . FOOD EXPO INGREDIENTS AFRICA FOOD Afmass EXPO The Future of Food in Africa JUNE 15-17, 2023 SARIT EXPO CENTRE, NAIROBI, KENYA
Safari Park Hotel, Nairobi, Kenya
AFRICA’S MOST INFLUENTIAL FOOD INDUSTRY AWARDS




ENTRIES
DEADLINE: MAY 1, 2023
FOOD
JUNE 16, 2023
A. COMPANIES OF THE YEAR 1. Company of the Year 2. Start-Up of the Year B. PEOPLE OF THE YEAR 3. CEO of the Year 4. Lifetime Achiever of the Year 5. Entrepreneur of the Year 6. Young Person of the Year (below 35 years) C. NEW PRODUCTS OF THE YEAR 7. Innovative Food Products of the Year 8. New Product with Most Outstanding Use of Ingredients 9. New Product with Most Outstanding Packaging 10. New Product with Most Outstanding Nutrition Application D. SUSTAINABILITY CHAMPIONS OF THE YEAR 11. Renewable Energy Initiative of the Year 12. Water & Waste Management Initiative of the Year 13. Local Sourcing Initiative of the Year 14. Community Initiative of the Year 2023 AWARDS CATEGORIES www.awards.foodbusinessafrica.com
CEREMONY
Food Safety
In this issue
4 Editorial 5 Events Calendar
10 News Updates:
• FDA to restructure Human Foods Program to establish proactive approach in tackling crisis
• National Agricultural Research Organization finds grains in Uganda laden with 10 times more aflatoxin
• Research shows Listeria species developing resistance to disinfectants used in food industry

• Kenya leads Africa in automating phytosanitary certification

• Ghanaian scientists working on inserting a second gene into Bt cowpea to strengthen pest resistance
• AOAC Sub-Saharan Africa expands scope to cover entire continent

• Screen-printed electrodes to aid in real-time detection of E.coli in milk

• Harvestplus Nigeria, Nigeria government unveil national Biofortification Recipe guide to address malnutrition
ON THE COVER
Dr. Roy Mugiira, CEO, National Biosafety Authority


19 Supplier News & Innovations:
• bioMérieux develops kit to simultaneously detect Listeria, Salmonella

• Enartis partners with WINEGRID to introduce “Smart Enology” hence increasing efficiency in wineriesw
• iFoodDS launches consultancy division to help firms implement FDA traceability rule

• Danfoss partners with Lizard Monitoring to assist North American stores reduce food waste
20 Appointments Update
MARCH 2023 | FOOD SAFETY AFRICA MAGAZINE FOODSAFETYAFRICA.NET 2
23 30 WORLD FOOD SAFETY DAY
NATIONAL BIOSAFETY AUTHORITY DR. ROY MUGIIRA We are ready to regulate GM foods in Kenya CRONOBACTER IN AFRICA SA’S LABELING REGULATIONS SALT SCIENCE & RESEARCH: SCIENCE & RESEARCH: REGULATORY: FORMULATION: INDUSTRY FOCUS: AOAC AFRICA DEBUTS PLATFORM WATER RE-USE IN DAIRY INDUSTRY WWW.FOODSAFETYAFRICA.NET YEAR 3 ISSUE NO. MARCH 2023
30
23 38 40 44 47 50
KNOW YOUR REGULATOR: National Biosafety Authority
Out of the freezer, into the limelight to take charge of the biotech sector
SCIENCE & RESEARCH: Foodborne Pathogens in Africa

Foodborne pathogens in Africa: Understanding Cronobacter sakazakii
OPINION: World Food Safety Day 2023
World Food Safety Day 2023 theme highlights the importance of food standards in protecting public health
FORMULATION: Salt
Salt, an all-time source of flavour proves to be a rising tingle of death, WHO report indicates

REGULATORY: South Africa's Labeling Regulations
South Africa’s draft labeling regulations envisioned to encourage better food choices


INDUSTRY FOCUS: Water Re-use in the Dairy Industry

Practical guidance on risk-based approaches to assess and manage fit-for-purpose water in the Dairy Industry
SCIENCE & RESEARCH: AOAC Africa
A collaborative approach to driving and delivering effective and sustained improvement in analytical laboratories

FOODSAFETYAFRICA.NET MARCH 2023 | FOOD SAFETY AFRICA MAGAZINE 3 MARCH 2023 | Year 3 Issue 1. No. 6
50 WORLD FOOD SAFETY DAY 40 47 38 44
Year 2 | Issue 1 | No.6
FOUNDER & PUBLISHER
Francis Juma
SENIOR EDITOR
Paul Ongeto
EDITOR
Catherine Odhiambo
BUSINESS DEVELOPMENT DIRECTOR
Virginia Nyoro
BUSINESS DEVELOPMENT ASSOCIATE
Hellen Mucheru
HEAD OF DESIGN
Clare Ngode
VIDEO & DESIGN ASSISTANT
Newton Lemein
ACCOUNTS
Jonah Sambai
PUBLISHED BY: FW Africa

P.O. Box 1874-00621, Nairobi Kenya
Tel: +254 20 8155022, +254725 343932
Email: info@fwafrica.net
Company Website: www.fwafrica.net

Exploiting GM technology’s food security potential, Africa waits to see Kenya’s game plan

If it's not safe, it's not food. You probably remember that phrase from the 2022 Africa Food Safety Summit where it was repeated by almost every speaker until it was impressed permanently on our minds. With the recent lifting of the ban on GM crops in Kenya, I couldn’t help but wonder: are GM crops safe? And if not, do they qualify as food? The potential for GM Crops to possibly relieve food shortages, particularly in sub-Saharan Africa where 146 million people are suffering from acute food insecurity and require urgent humanitarian assistance, is enormous.
The use of high-yielding, diseaseand pest-resistant crops, is for instance projected to have a direct bearing on improved food security, poverty alleviation, and environmental conservation. GM crops will hopefully produce more yield on less land. This may increase overall productivity and may offer developing countries a means to sustain themselves and reduce worldwide hunger.
However, serious questions surrounding its safety still linger with many associating GM crops with negative health outcomes some as bizarre as men growing breasts and women growing beards! This just shows the level of negative perception towards GM crops. As Kenya works to adopt GM technology, the task is on the National Biosafety Authority to assure the public of their safety when consuming GM
foods. The pressure on the Authority is immense as Africa is watching Kenya’s steps closely, and its failure or success will play a key role in determining whether widespread adoption of the novel technology will become a reality during our lifetime.


In this Magazine, we explore the ups and downs of rolling out GM technology in Africa with National Biosafety Authority’s CEO, Dr. Roy Mugiira. As food recalls associated with Cronobacter sakazakii spike, we also explore how food processors in Africa can prevent transmission of the bacteria along the food production chain.
We sure believe these along other articles on water reuse in dairy plants, labeling regulations, and sodium reduction will be worth your read.
We wish you an insightful read,
Paul Ongeto, Senior Editor FW Africa
MARCH 2023 | FOOD SAFETY AFRICA MAGAZINE FOODSAFETYAFRICA.NET 4 Food Safety Africa is published 4 times a year by FW Africa. Reproduction of the whole or any part of the contents without written permission from the editor is prohibited. All information is published in good faith. While care is taken to prevent inaccuracies, the publishers accept no liability for any errors or omissions or for the consequences of any action taken on the basis of information published. EDITORIAL WWW.FOODSAFETYAFRICA.NET CEO BUSINESS AFRICA WWW.HEALTHCAREMEA.COM WWW.SUSTAINABLEPACKAGINGAFRICA.COM WWW.CEOBUSINESSAFRICA.COM OUR PUBLICATIONS MILLING MIDDLE EAST & AFRICA WWW.FOODBUSINESSAFRICA.COM WWW.MILLINGMEA.COM
Business HealthCare MIDDLE EAST & AFRICA
Food Africa
WWW.FOODSAFETYAFRICA.NET
AOAC Africa Section Annual Conference
29-31 March 2023
Johannesburg, South Africa
www.foochemistry.www.aoac-africa. org/2023-annual-meeting
Australian Food Microbiology Conference
30 Mar 2023
Parramatta, Australia
www.aifst.asn.au/AIFST-2023-FoodMicrobiology-Conference
Annual American Food Sure Summit
30 - 31 Mar 2023
Chicago, USA1 www.americanfoodsure.com
International Conference on Food Microbiology
05 - 06 Apr 2023
Barcelona, Spain
https://foodmicrobiology. foodtechconferences.com
Annual Canadian Summit on Food Safety
18 - 19 Apr 2023
Mississauga, Canada
www.foodsafetycanada.com
World Congress on Food Safety and Nutrition Science

27 - 28 Apr 2023
Rome, Italy
https://foodcongress. conferenceseries.com/
2023
International Conference on Food Microbiology and Food Safety (ICFMFS)
29 – 30 Apr 2023
Bali, Indonesia
http://theires.org/Conference2023/ Indonesia/3/ICFMFS/
Food Safety Summit Conference & Expo
08 - 11 May 2023
Rosemont, USA.
https://www.food-safety.com/foodsafety-summit

Food Safety Congress
25 - 26 May 2023
Berlin, Germany
https://live.handelsblatt.com/event/ food-safety-kongress/
International Conference and Expo on Food Science and Food Safety
12 - 13 Jun 2023
Paris, France
https://hilarisconferences.com/ foodscience

Africa Food Safety & Nutrition Summit
14 - 17 June
Nairobi, Kenya
https://summit.foodsafetyafrica.net
The International Conference on Agriculture, Food Security and Safety (AgroFood)
14 - 15 Jul 2023
Colombo, Sri Lanka
2023
https://agrofoodconference.com/
Meat Industry Food Safety Conference
17 - 18 Aug 2023
Denver, USA.
https://www.meatinstitute.org/ht/d/ sp/i/181624/pid/181624
International Conference On Food Science and Nutrition (ICNSFT)
25 - 26 Aug 2023
London, UK.
https://www.aconf.org/conf_189395. html
North American Food Safety & Quality (NAFS)

26 - 27 Sep 2023
Buffalo Grove, USA
https://foodsafetyna.com/
Food Safety Consortium Conference & Expo;
16 - 18 Oct 2023
Parsippany-Troy Hills, USA
https://foodsafetyconsortium.org/
FOODSAFETYAFRICA.NET MARCH 2023 | FOOD SAFETY AFRICA MAGAZINE 5 EVENTS CALENDAR
2023
JUNE 15-17, 2023
Nairobi, Kenya
www.summit.foodsafetyafrica.net

DISCOVER THE FUTURE OF FOOD SAFETY, NUTRITION & FOOD SECURITY IN AFRICA
REASONS TO ATTEND THE SUMMIT
Provide a platform to exchange the latest knowledge, experience and expertise in food safety, food nutrition, food processing and new technologies within the food and agro value chains in Africa


Improve local, regional and global collaboration initiatives on food nutrition, food security and food safety initiatives;
Provide a platform where technology and service providers can showcase their latest products and services to the industry, Goverment/NGOs and other stakeholders, hence improving the adoption of the latest technologies in Africa’s food and agro sector;
Improve the quality and food safety aspects of the food, agricultural and processed food and feed products in Africa, hence boosting trade and market access to local, regional and overseas markets;
Amplify the awareness of consumers on food safety, regulatory and public health issues and how each stakeholder can contribute to a safer food environment in the Continent.




7 info@fwafrica.net +254 725 343 932 www.summit.foodsafetyafrica.net Sign up to Sponsor, Attend & Speak SCAN ME
FAO harmonizes antimicrobial resistance frequently used vocabulary to ease communication
of frequently used terms on the subject of antimicrobial resistance (AMR) to better align technical internal communications and materials for external audiences.
The terms are now available, in addition to other languages, in all six of the UN’s official languages: Arabic, Chinese, English, French, Russian, and Spanish.
led the working group to define the terms.
The vocabulary is also accessible in Khmer, Korean, Mongolian, and Nepali, the four official languages of the nations participating in the “Action to support implementation of Codex AMR Texts (ACT)” project.
Soon, it will be accessible in Punjabi and Urdu.
GLOBAL – The Food and Agriculture Organization (FAO) has created a glossary
”Having clear and precise definitions of words, and using them carefully, is particularly important when diverse stakeholders engage in discussions so that everyone has the same understanding of the intended message,” said Jeffrey LeJeune, FAO Food Safety Officer, who
“Words matter. Considering the complexity of the AMR issue, having harmonized terminology is a helpful contribution when working together in the fight against AMR,” said Jorge Pinto Ferreira, FAO Food Safety Officer.
FDA to restructure Human Foods Program to establish proactive approach in tackling crisis
U.S – To better assist the organization as a whole, the U.S. Food and Drug Administration (FDA) has unveiled a new, transformative vision for the Human Foods Program and the Office of Regulatory Affairs (ORA).
The concept calls for the establishment of a consolidated Human Foods Program with a single Director reporting directly to the FDA Commissioner, eliminating
DISEASES, OUTBREAKS & RECALLS
duplications, and empowering the organization to regulate human food more effectively and efficiently.
Interestingly, these changes come hot on the tail of the FDA’s Deputy Commissioner, Food Policy and Response, Frank Yiannas’s resignation.
While penning his resignation, the Deputy Commissioner cited that the decentralized structure of the foods
UK records dramatic rise in norovirus cases
U.K – The UK Health Security Agency (UKHSA) has reported a dramatic rise in confirmed norovirus cases, registering a 66 percent rise higher than the seasonal norm.


The total number of lab reports for weeks 3 and 4 of the 2022–2023 norovirus season was 527, which is more than the 318 reports seen on average during the previous five seasons for the same twoweek period.
People 65 and older are experiencing the largest increase in lab-confirmed norovirus cases. UKHSA noted that such high levels in this age range had not been observed in over ten years.
Hospitals, schools, and nursing homes have all seen an upsurge in norovirus outbreaks, with nursing facilities
program significantly impaired the FDA’s ability to operate as an integrated food team and protect the public.
As such, he recommended the creation of a more integrated operating structure and a fully empowered and experienced Deputy Commissioner for Foods, with direct oversight of those centers and offices responsible for human and animal foods.
reporting the majority of cases. In hospitals, 78 outbreaks were lab-verified as norovirus up until week 4 of the 2022–2023 season.
To this end, UKHSA notes that maintaining proper hand hygiene is among the best strategies to stop the spread.
“Regular handwashing is really important to help stop the spread of this bug, but remember, alcohol gels do not kill off norovirus so soap and warm water are best,” said Lesley Larkin, Surveillance Lead for the Gastrointestinal Infections and Food Safety (One Health) Division at UKHSA.
MARCH 2023 | FOOD SAFETY AFRICA MAGAZINE FOODSAFETYAFRICA.NET 8 NEWS UPDATES
REGULATORY & POLICY
National Agricultural Research Organization finds grains in Uganda laden with ten times more aflatoxins
good fungus, it displaces the bad one in a process known as competitive exclusion and this is the principle we used to develop aflasafe,” Dr. Godfrey Asea, the Director of Research at the National Crops Resources Research Institute (NaCRRI), said in reference to a biological product used to reduce aflatoxins.
Harvestplus Nigeria, Nigeria government unveil national Biofortification Recipe guide to address malnutrition

UGANDA – Scientists at the National Agricultural Research Organization (NARO) have found that maize, sorghum, and groundnuts in Uganda have aflatoxins concentrations that are 10 times or greater than the safety level advised by the World Health Organization (WHO).

The investigation was carried out by government experts in collaboration with the International Institute of Tropical Agriculture to determine the aflatoxin level in the grains from 2007 to 2023. Both the soil and the grains were examined as part of the investigation.
“We got both good and bad fungi. When you have a high concentration of
He revealed that the country produces about five million metric tonnes of grain per year and from the research, samples of these grains contain up to 100 parts per billion of aflatoxins, which is higher than the 10ppb recommended by WHO.
Ghana Artisanal Palm Oil Millers and Outgrowers Association launches app to curb palm oil adulteration
GHANA – The Food and Drugs Authority (FDA) in cooperation with the Artisanal Palm Oil Millers and Outgrowers Association, has launched the Artisanal Palm Oil app in Accra to ensure that only authentic and healthy palm oil is sold in the Ghanaian market.
The event organized by the Artisanal Palm Oil Millers and Outgrowers Association was under the theme, ‘Introducing Digital Technology into the Palm Oil Industry to curb the menace of Sudan IV’.
Sudan dyes are classified by the International Agency for Research on
Cancer (IARC) as Group 3 carcinogens and are banned as food additives worldwide (IARC, 1987).
The dye is widely used during the processing of non-food products such as textiles, leather, plastics, papers, hair, mineral oils, waxes, and cosmetics.
The app has tools to determine whether the FDA has approved the brand of palm oil represented by the QR code. It may also show details about the palm oil producers, including their locations and photos so that customers can quickly determine where the product came from.
NIGERIA – Bio-fortification giant, HarvestPlus Nigeria, in collaboration with the federal government and development partners, has launched the first national nutritional guide to help Nigerians reduce the risks of malnutrition that has been grappling Africa’s most populous country.
The Minister of Agriculture and Rural Development, Dr. Mahmood Abubakar has termed the National Biofortification Recipe Book titled ‘Biofortification on my Plate’ a game-changer.
He expressed confidence that the information contained in the book addresses the healthy eating and dietary diversity of Nigerians.
The first national 201-page recipe book includes nutrient-enriched foods and features a collection of practical and traditional dishes that have been cleverly adapted to meet the daily nutrition needs of all family members and to provide a diverse menu using bio-fortified crops, aiming to improve nutrient intake and reduce malnutrition.
The book offers over 50 recipes using vitamin A cassava, vitamin A maize, and vitamin A orange sweet potatoes as the main ingredients, Abubakar said.
“BIOFORTIFIED CROPS ON MY PLATE’ features a collection of practical and traditional dishes that have been cleverly adapted to provide added nutrition and fight malnutrition through bio-fortified foods,” said Chief Nutritionist of HarvestPlus, Erick Boy.
FOODSAFETYAFRICA.NET MARCH 2023 | FOOD SAFETY AFRICA MAGAZINE 9
SCIENCE & RESEARCH NEW TECHNOLOGY
UGANDA'S CEREALS HAVE AFLATOXINS CONCENTRATIONS THAT ARE 10 TIMES OR GREATER THAN THE SAFETY LEVEL ADVISED BY THE WHO
The Future of Food in Africa

www.afmass.com
JUNE 15-17, 2023
Sarit Expo Centre, Nairobi, Kenya
SIGN UP TO ATTEND EASTERN AFRICA'S LARGEST FOOD, BEVERAGE & MILLING INDUSTRY TRADE SHOW

Co-located with:
Sign up today to Sponsor, Exhibit, Speak or Attend AFMASS Food Expo
Hosted at the Sarit Expo Centre in Nairobi, Kenya on June 15-17, 2023, AFMASS Food Expo has over the last 7 years grown into the most influential trade show for the food, beverage and milling industry in Eastern Africa.
This year, look forward to a larger Expo Hall with more exhibitors, a larger variety of exhibitors from more than 20 countries and more food companies showcasing their latest products
And to cap it all, join us as we debut the AFMASS Baking Championship at the Expo. See you in June!!
FOOD Afmass EXPO
info@fwafrica.net +254 725 343 932 www.afmass.com Sign up to Sponsor, Attend & Speak SCAN ME
FOUR PAVILLIONS THAT COVER THE FOOD INDUSTRY FROM A-Z
AFMASS BakingChampionship

• The AFMASS Baking Championship is a new initiative by the organisers of the AFMASS Food Expo that is focused on promoting excellence in the bakery industry in Africa.

• The Championship’s main goal is the advancement of the baking and baking profession in Africa and to create vibe and celebration at this pan-African Expo.
In the first edition, the Championship will focus on the cake making and decoration – where creativity, science and art converge, thereby enabling attendees to experience the wonderful art of baking.

The competitors will be judged by a Panel of Judges with vast experience in the field of pastry, cake making and baking, with each entry evaluated on originality and creativity in the use of ingredients, decoration and the use of technical skills. They will also be judged on cleanliness and overall presentation of the final cake.
FOOD

AFMASS DRINKS

PACK AFRICA EXPO Process &
FOOD EXPO INGREDIENTS AFRICA
MARKET
NEW
AOAC Sub-Saharan Africa expands scope to cover entire continent
Screen-printed electrodes to aid in realtime detection of E.coli in milk
UK/NETHERLANDS – Escherichia coli can now be detected in milk without sample preparation thanks to the development of a unique thermal biosensor for real-time detection.
The approach is based on screenprinted electrodes (SPEs), which are functionalized via a straightforward surface-imprinting method. This method is an easily scalable method for producing synthetic receptors.
Due to their affordable and scalable production procedure, SPEs have recently grown in popularity for use in biosensor applications. The SPEs were used in combination with the heat transfer method to detect E. coli.
The sensor was tested in milk samples
that had been inoculated with E. coli without the requirement for sample preparation in order to demonstrate the sensor’s usefulness. The outcomes matched those of a buffer experiment.
Overall, the sensor enables the labelfree quantification of the pathogen using experimental protocols that call for little to no apparatus, as well as the real-time detection of E. coli.
The study was a combined effort of researchers from the Sensor Engineering Department, Faculty of Science and Engineering, Maastricht University, and Faculty of Science and Engineering, Manchester Metropolitan University, United Kingdom.
SOUTH AFRICA – Analytical scientists working throughout the African continent will now be included in AOAC Africa’s purview following considerable consultation with its 300+ members and ultimate approval from AOAC INTERNATIONAL.

Formerly known as the AOAC SubSaharan Africa Section, AOAC Africa focused, as the name suggested, on scientists in the nations south of the Sahara.
Building trust in analytical results, the AOAC Sub-Saharan Africa Section is a premier regional professional scientific association committed to furthering knowledge and best practices in the analytical sciences throughout the region.
It comprises not only industry veterans, but also young scientists who participate in its annual meetings, ensuring recognition of AOAC, and succession in the future.
AOAC Africa will from now onwards serve individuals working to ensure food safety and compliance with applicable regulations throughout the continent.
Dr. Owen Fraser, President, AOAC Africa, noted that the expansion comes at an opportune time when the African Continental Free Trade Area (AfCFTA) is bringing with it regulatory challenges and opportunities that are not restricted to one region but apply to Africa as a whole.
REGULATORY & POLICY
WHO report on global trans fat elimination 2022 shows 2023 target unachievable

to track progress towards the goal of trans fat elimination in 2023.
Population coverage of best-practice policies has expanded about six-fold since WHO initially advocated for the global eradication of industrially produced trans fat in 2018 with an elimination target set for 2023.
As per the report, 2.8 billion people are now safeguarded worldwide thanks to 43 nations that have adopted best-practice laws to combat trans fats in food.
However, despite significant progress, this still exposes 5 billion people to the devasting health effects of trans fat, making the global target for its complete eradication in 2023 now unachievable.
SWITZERLAND – The World Health Organization (WHO) status report has revealed that about five billion people globally remain unguarded from harmful trans fat, increasing their risk of heart disease and death.
The report, called “Countdown to 2023 – WHO report on global trans fat elimination 2022”, is an annual status report published by WHO in collaboration with Resolve to Save Lives,
“Trans fat has no known benefit and huge health risks that incur huge costs for health systems. By contrast, eliminating trans fat is cost-effective and has enormous benefits for health.
“Put simply, trans fat is a toxic chemical that kills and should have no place in food. It’s time to get rid of it once and for all,” said WHO Director-General, Dr. Tedros Adhanom Ghebreyesus.
MARCH 2023 | FOOD SAFETY AFRICA MAGAZINE FOODSAFETYAFRICA.NET 12
NEW TECHNOLOGY
NEWS
UPDATES
FDA publishes draft guidelines for labeling plant-based foods
statement that describes how the product compares with milk using the U.S. Department of Agriculture’s (USDA’s) Food and Nutrition Service fluid milk substitutes nutrient criteria.
For instance, the label might read, “Contains lower amounts of Vitamin D and calcium than milk.”
The FDA is also developing a draft guidance to address the labeling and naming of other plant-based alternatives and is seeking comments on the same.
U.S – The U.S. Food and Drug Administration (FDA) has published draft guidelines for the industry on the naming of plant-based foods marketed and sold as milk substitutes.

The draft guidance titled Labeling of Plant-based Milk Alternatives and Voluntary Nutrient Statements: Guidance for Industry, also suggests that some plant-based milk substitutes’ labels include voluntary nutrient claims.
SCIENCE & RESEARCH
The proposed guidance was created to address the enormous rise of plantbased milk substitutes that have occurred over the past ten years in the market. The guidelines are designed to give consumers clear labeling.
According to the draft guidance, a plant-based milk alternative product with the term “milk” in its name (such as “soy milk” or “almond milk”) and that has a different nutrient composition from milk should include a voluntary nutrient
All 15 samples of water that were randomly obtained from the butcheries and eateries tested positive for E. coli, salmonella spp., and Shigella bacteria, according to the report written by principal investigators Dr. Hillary Odeckh Indago, Prof. Joseph Wafula Matofari, and Dr. John Masani Nduko.
“These results indicate a public health risk for consumers of RTE meat products in Nakuru County,” the report stated.
“The presence of these bacteria points a direct finger to bad handling and poor hygiene practices because they indicate that the products have been in contact with faecal matter.”
Research shows Listeria species developing resistance to disinfectants used in food industry
SOUTH AFRICA – A study conducted in South Africa and recently published in the journal Microbiology Spectrum has concluded that Listeria innocua strains are developing resistance to temperature, pH, dehydration, and other stresses.
The study used whole-genome sequencing to provide insights into two species of presumed nonpathogenic Listeria—L. innocua and L. welshimeri.
Some of the L. innocua and L. welshimeri strains tested for the study exhibited three genes for resistance to a common disinfectant from the class of chemicals known as quaternary ammonium compounds (QAC or QUAT).
The study included 258 isolates from butcheries, abbatoirs, retail
establishments, cold storage facilities, and processing facilities located throughout South Africa.
Of these, three isolates of nonpathogenic L. welshimeri and 38 isolates of nonpathogenic L. innocua were identified. Additionally, two of the L. innocua strains examined in the study had three or more pathogenic traits that were alarming, including CRISPR CAStype adaptive immune systems.
“The Listeria innocua that we tested has some of the genes that are also found in pathogenic Listeria monocytogenes.
“These shared genes between L. innocua and L. monocytogenes are also responsible for disease in humans and stress tolerance such as resistance to the disinfectant Benzalkonium chloride,”
said Thendo Mafuna, Ph.D., a Lecturer at the University of Johannesburg, and coauthor of the study.
FOODSAFETYAFRICA.NET MARCH 2023 | FOOD SAFETY AFRICA MAGAZINE 13 REGULATORY & POLICY
THE LISTERIA INNOCUA THAT WE TESTED HAS SOME OF THE GENES THAT ARE ALSO FOUND IN PATHOGENIC LISTERIA MONOCYTOGENES.
Thendo Mafuna, Ph.D., a Lecturer at the University of Johannesburg
Kenya leads Africa in automating phytosanitary certification
problems with documentation.
The ePhyto platform is anticipated to decrease the cost experienced by exporters with physical documentation as well as the time it takes for the document to be transmitted from Kenya to the Netherlands and other markets.
KEPHIS backs the system to also improve phytosanitary certification compliance by at least 99%.
KENYA – Thanks to a platform created in conjunction with the Netherlands Food and Consumer Safety Authority (NVWA) that has automated phytosanitary certification, the Kenya Plant Health Inspectorate Service (KEPHIS) anticipates an increase in the volume of horticultural exports from Kenya.
Prof. Theophilus Mutui, the Managing Director of KEPHIS, claimed that the ePhyto platform will assist in reducing instances of missing documentation, inaccurate information, incomplete documentation, and forgeries that have

plagued Kenya’s export process and resulted in losses for producers and income for the government.
“Previously we have had challenges where there is fraud. People have defaced the phytosanitary certificates which has led to our products being intercepted at the destination market. This is the reason why we came up with this innovation to be able to address that challenge,” said Prof. Mutui.
According to KEPHIS, horticulture exports are typically seized in at least 54 consignments each year because of
Ghanaian scientists working on inserting a second gene into Bt cowpea to strengthen pest resistance
GHANA – The National Biosafety Authority (NBA) has received a new application from researchers at the Council for Industrial and Scientific Research (CSIR) and the Savanna Agricultural Research Institute (SARI) in Ghana asking for permission to add a second gene to the cry1Ab that has already been inserted into the Bt cowpea.
According to them, the new cry2Ab gene will strengthen and increase the Bt cowpea’s resistance to the Maruca pest and any potential future mutations.
SARI has spent more than ten years working to genetically alter the popular cowpea variety songotra to withstand the pod-boring bug Maruca vitrata.
Insects do evolve into new biotypes
and dismantle any previously developed resistance, according to SARI Director Dr. Francis Kusi.
“So, with this approach, we are just trying to build up the level of genes in there so that if a particular insect can overcome one, the other one will be able to knock it out.
“This is the approach, and that is why we are now asking for the second gene to add to make it more robust, and then the resistance can stay longer for the farmers,” he said.
The biosafety authority authorized the release of the Bt cowpea into the environment on June 30, 2022.

MARCH 2023 | FOOD SAFETY AFRICA MAGAZINE FOODSAFETYAFRICA.NET 14
TECHNOLOGY
NEWS UPDATES
THE EPHYTO PLATFORM IS ANTICIPATED TO DECREASE THE COST EXPERIENCED BY EXPORTERS WITH PHYSICAL DOCUMENTATION AS WELL AS THE TIME IT TAKES FOR THE DOCUMENT TO BE TRANSMITTED FROM KENYA TO THE NETHERLANDS AND OTHER MARKETS.
AFRICA
BUSINESS SUMMIT
MARCH 13-15, 2024
Nairobi, Kenya
Accelerating Businesses Innovation, Strategic Leadership & African Transformation through new Technologies
The Africa Business Summit is the ground-breaking conference and exhibition that brings together the key decision makers to define the future of business innovation, strategic leadership and the transformation of Africa, as we approach 2030 and beyond.
KEY AGENDAS
The conference program at the 3-day Summit will comprise of highlevel keynote speeches and panel discussions plus sponsored industry and country-focused sessions. It will also feature fireside chats with influential people and change makers who are making waves –and who are also inspiring the next phase of business leaders in the Continent.
 The Africa CEO & Leadership Forum
The Africa CEO & Leadership Forum
Digitizing Africa Strategic Leadership in Africa Connecting & Trading In Africa Healthier Africa Industralising Africa Investing In Africa Sustainable Africa Powering Africa Feeding Africa
* * www.africabusinesssummit.biz
Neogen’s Reveal 3-D for Gluten receives AOAC certification
U.S – The AOAC Research Institute has awarded the Performance Tested Method Certification to Neogen Corporation for their Reveal 3-D for Gluten test.
The Reveal 3-D for Gluten test has been independently verified as meeting the AOAC standard for screening gluten residues in environmental samples by the AOAC certification (No. 122201).
Neogen’s Reveal 3-D for Gluten is a single-step lateral flow immunochromatographic assay that utilizes a simple, rapid methodology to qualitatively detect gluten residues in environmental and food samples as low as 5 parts per million (ppm).
develops kit to simultaneously detect Listeria and Salmonella
U.S – bioMérieux, a global pioneer in invitro diagnostics, has developed a firstof-its-kind testing kit that simultaneously detects Listeria and Salmonella from environmental swabs, with PCR confirmation.
The technology reduces laboratory waste, lowers costs, and streamlines the workflow to enable quick and accurate quality decisions.
Separate enrichments are used in the market-available processes and tests for Salmonella and Listeria.
With the help of GENEUP ENVIROPRO, users may test environments for both Salmonella and Listeria with just one swab, one enrichment, and one sample preparation, increasing total sampling efficiency and sustainability.
The GENE-UP ENVIROPRO assay is the outcome of bioMérieux’s xPRO program, an innovation engine within bioMérieux that collaborates directly with industry leaders to quickly develop, validate, and commercialize cutting-edge molecular assay to address new market
AWARD
“With this certification, we once again demonstrate the continued reliability of our assays and our commitment to providing trustworthy, dependable solutions for producers around the world.
“Our customers can confidently utilize our Reveal 3-D for Gluten tests to help gluten-intolerant and allergic customers minimize exposure to allergens,” said John Adent, Neogen’s President and Chief Executive Officer.
The assay delivers results in just 5 minutes and can be used in virtually any environment to screen environmental swabs and clean-in-place rinses.
The Reveal 3-D line of food allergen test kits is uniquely designed to guard against oversaturation and false negative results, with results displayed in three visual lines on the lateral flow test strip.

needs and improve their overall quality programs.
“The evolution of ENVIROPRO demonstrates our commitment to innovation through our xPRO program and our success in building gamechanging assays.
“Bringing much-needed efficiencies to routine environmental monitoring will not only reduce costs for our end users but do so in a far more sustainable way, a key focus in the market,” said Ben Pascal, Global Head xPRO Program, bioMérieux.

SGS India receives 13th Food Safety Award 2022 for Outstanding Laboratory Performance
INDIA – SGS Testing laboratory based in Ambattur, Chennai has been awarded the 13th Food Safety Award 2022 for Outstanding Laboratory Performance – Food Testing Laboratories by the Confederation of Indian Industry (CII) –Food and Agriculture Center of Excellence (FACE) – India’s leading resource center for driving food safety and nutrition in the food processing industry.
The CII Award for Food Safety, which was introduced by CII in 2010, fosters the development of capacity along the food value chain while promoting globally recognized practices in food safety in small, medium, and large food businesses.
The performance of food testing laboratories is assessed using ISO
17025:2017 standards, best practices, leadership efforts, and social and legal compliance.
SGS’s state-of-the-art food testing laboratory in Ambattur, Chennai is ISO/IEC 17025:2017 accredited for a scope covering a wide range of tests on agriculture and food products. It is also certified for ISO 9001:2015, ISO 45001:2018, and ISO 14001:2015.
The lab can conduct nutritional analysis, pesticides (+1000), mycotoxins, heavy metals, illegal dyes, antioxidants, preservatives, pathogens, and nonpathogens in food as well as digital sensory evaluation, species identification, and shelf-life studies to test the quality of agricultural and food products.
MARCH 2023 | FOOD SAFETY AFRICA MAGAZINE FOODSAFETYAFRICA.NET 16 NEW TECHNOLOGY
bioMérieux
SUPPLIER NEWS & INNOVATIONS
Enartis partners with WINEGRID to introduce “Smart Enology” hence increasing efficiency in wineries

Enartis is now distributing will allow winemakers to make better decisions, enhancing the efficiency of their wineries in keeping with Enartis’ aim to support wineries throughout the world in achieving ever-higher wine quality.
Due to advanced forecasting and analytical capabilities, the company notes that winemakers will be able to quickly take remedial action in situations where the parameters are not optimal.
Enartis.
ITALY – Enartis, an Italian multinational operating in the market of enological products and services, has partnered with WINEGRID, a Portuguese engineering company specializing in winemaking monitoring solutions, to distribute WINEGRID innovative solutions worldwide which detect critical production data in real-time during the various stages of winemaking.
The WINEGRID technology that
A proprietary information system on a SaaS (Software as a Service) platform analyzes and interprets the acquired data using cutting-edge algorithms and Artificial Intelligence (AI) technology.
“This partnership meets our primary vocation of always being one step ahead in our industry. The interaction with the most advanced forms of technology proposed by WINEGRID, including Artificial Intelligence, allows us to offer, not only solutions and control but the strategic design of wines with a systematic and scientific approach,” says Piermario
Ticozzelli, Strategic Business Director of
THE INTERACTION WITH THE MOST ADVANCED FORMS OF TECHNOLOGY PROPOSED BY WINEGRID, INCLUDING ARTIFICIAL INTELLIGENCE, ALLOWS US TO OFFER THE STRATEGIC DESIGN OF WINES WITH A SYSTEMATIC AND SCIENTIFIC APPROACH.
Piermario Ticozzelli, Strategic Business Director of Enartis.
Danfoss partners with Lizard Monitoring to assist North American stores reduce food waste
DENMARK/U.S – To assist North American stores reduce food waste, Danish multinational company Danfoss has established a cooperation with U.S retail technology company Lizard Monitoring.
The Alsense monitoring system from Danfoss is reported to be supplemented by The Lizard’s sensor networks to enable continuous temperature monitoring and deliver in-depth information on environmental compliance and refrigeration performance to store managers and food safety executives.

Retail managers can monitor refrigeration performance using Danfoss’ Alsense, an Internet of Things (IoT) platform developed within Microsoft Cloud for Sustainability. This platform
tracks alarms ensures continuous monitoring of food conditions and lowers energy use.
Lizard offers reliable wireless sensor networks to gather information from
retail settings and deliver it to the cloud where it is mined for trends that will cause food waste before they occur.
To this end, customers can now get more thorough records of each event and what shop personnel did in response, along with early warnings and fewer alarms.
“Our customers are looking for sustainable solutions and more automation to reduce product loss and labor and energy costs.
“The Lizard solution is highly complementary to the Danfoss Alsense platform and together gives a 360-degree view of your store’s refrigeration performance,” commented Peter Dee, Danfoss North America Sales Director of Food Retail.
FOODSAFETYAFRICA.NET MARCH 2023 | FOOD SAFETY AFRICA MAGAZINE 17 DISTRIBUTION PARTNERSHIP
Energis Solutions develops technology to reduce pathogens in meat
Document Compliance Network releases new edition of its food safety software traceability rule
U.S – In order to help food safety teams in the food and beverage sector work more efficiently and with less work, Document Compliance Network (DCN), a cloudbased solution that makes managing food safety documentation easier, has released a new edition of its food safety software.

There are 14 languages supported by DCN’s food safety software, including Arabic, Chinese, English, French, German, Hindi, Italian, Japanese, Korean, Portuguese (Brazil), Russian, and Spanish.
U.S – The Voltai technology for the meat protein sector invented by biotechnology company Energis Solutions, has been independently validated and submitted to the Food and Drug Administration (FDA) for clearance.
The solution is manufactured onsite using a machine that can be simply integrated into almost any current production process and significantly reduces food-borne pathogens that continue to pose a threat to the meat sector.
“The Voltai machine produces a patented unique, highly energized fluid that carries the same EPA toxicity rating as tap water, Category IV. The technology can be used as a carcass spray or poultry dip, which is far safer than acid-based alternatives that are often used in the industry today,” said Darin Jensen, Vice President of Food Safety, Quality & Regulatory, Energis.
The Voltai solution targets STEC, Salmonella, Campylobacter, and Listeria amongst other pesky pathogens.

It is Kosher and Organic compliant and is in current trials validating shelflife extension characteristics for protein products.
Voltai has conducted multiple 3rd party side-by-side studies that prove double the reduction of STEC and Salmonella when compared to legacy Peracetic and Lactic acid treatments.
In addition, you can designate the preferred language of your business partner (customer or vendor) to streamline communication and efficiency in the global supply chain.
DCN also modified its internal
document area to incorporate a history and change log, making it simple to track updates to Standard Operating Procedures (SOPs) as required by various auditing organizations and food safety requirements.
For the supplier side of the platform, the upgrade also adds a history and advanced note system that will automatically move earlier iterations of documents into history and keep track of who approved them.
Food and beverage businesses can submit their most recent papers to the program, which will automatically deliver them to associated customers before they expire, and send one-way fillable PDFs to suppliers.
launches consultancy division to help firms implement FDA traceability rule
iFoodDS
U.S – In order to help businesses achieve operational compliance with the FSMA 204 mandate, iFoodDS, the industry leader in connected traceability, quality, and food safety solutions for the fresh food supply chain, has announced the formation of a consultancy division called New Era Partners.
The Food Safety Modernization Act Section 204 Food Traceability Rule, recently published by the FDA, establishes new traceability recordkeeping requirements for firms that manufacture, process, pack, or hold certain foods on the Food Traceability List.
New Era Partners will be coled by Matt Regusci, a co-founder of Azzule|PrimusGFS, and Andrew Kennedy, a former FDA traceability expert who worked on the development of FSMA 204.
According to iFoodDS, no team is better suited to assist businesses with the regulatory and practical implications of the new regulation and the best ways to comply.
“FSMA 204 is complex, especially
for grocers, foodservice operators, and processors. With our deep understanding of the rule and the supply chain, New Era Partners can quickly help enterprises understand the rule’s impact on their operations and objectively identify paths to compliance,” said Andrew Kennedy, Principal Traceability Advisor at New Era Partners.
Some of the services offered include executive briefings for enterprise operations, IT, and legal executives on the rule and its impacts, and Supply Chain Traceability X-Ray.
MARCH 2023 | FOOD SAFETY AFRICA MAGAZINE FOODSAFETYAFRICA.NET 18
CAPACITY BUILDING TECHNOLOGY UPDATE SUPPLIER NEWS & INNOVATIONS
FOOD AFMASS DRINKS
MARKET
The AFMASS Food & Drinks Market showcases packaged food products from Africa and the World. Sign up today to engage with consumers, corporate buyers from hotels, restaurants and catering (HORECA) and other institutions and more . . .






FOODSAFETYAFRICA.NET MARCH 2023 | FOOD SAFETY AFRICA MAGAZINE 19 WWW.AFMASS.COM JUNE 15-17, 2023 SARIT EXPO CENTRE, NAIROBI, KENYA
Dairy Products • Coffee & Tea • Poultry & Fish • Fresh Produce • Soft & Alcoholic Beverages • Flours, Legumes & Grains • Baked Goods & Snacks • Nuts, Oils & Oilseeds • Animal Feed & Pet Food • Savoury & Condiments • Fats & Oils etc . . . A SPECIAL PAVILLION AT: FOOD
EXPO The Future of Food in Africa
Afmass
Cindy McCain to head United Nations World Food Programme
Comoros President Azali Assoumani elected new AU Chair
AFRICA – The President of the Union of Comoros, H.E. Azali Assoumani, has been chosen by the Heads of State and Government of the African Union (AU) to serve as the new Chairperson of the African Union for the year 2023.

President Azali of Comoros is taking over the baton of command from H.E. Macky Sall, President of the Republic of Senegal, who has concluded his term as the Chairperson of the African Union for the year 2022.
Azali expressed his gratitude for the honor, responsibility, and trust placed in him and the other members of the new Bureau to guide the Organization’s course for the upcoming year in his acceptance address.
AOAC International appoints new Deputy Executive Director and Chief Science Officer
ITALY – United Nations World Food Programme (WFP), the world’s largest humanitarian organization, has tapped the current United States Permanent Representative to the UN Agencies in Rome, Cindy McCain as its new Executive Director, effective April.

McCain will succeed David Beasley as Executive Director, who will have served six years when his term ends on April 4.
She is the former Chair of the Board of Trustees of the McCain Institute for International Leadership at Arizona State University.
She also served on the Board of Directors of Project C.U.R.E., CARE, Operation Smile, the Halo Trust, and the advisory boards of Too Small To Fail and Warriors and Quiet Waters.
McCain holds an undergraduate degree in Education and a Master’s in Special Education from the University of Southern California.
Commenting on her appointment, McCain said: “I am ready to roll up my sleeves and spend time both in Rome and in the field, deepening my understanding of WFP’s vital work, and making sure it continues to grow to meet the needs of a hungry world.”
Kenya had earlier withdrawn its candidature from the elections, paving the way for Comoros to rise to the leadership ranks for the very first time in history.
“By allowing the Union of Comoros to lead the African continent, our Organization has just proved to the world its conviction that all countries have the same rights and enjoy the same freedoms,” underscored the incoming Chair of the Union.
U.S – AOAC International has appointed Dr. Katerina (Kate) Mastovska as the new Deputy Executive Director and Chief Science Officer.

AOAC International is a wellknown, impartial, third-party, notfor-profit organization that creates voluntary chemical and microbiological consensus standards.
“I’m delighted to join the AOAC staff and lead the team of dedicated scientists. AOAC has a critical role in food safety, and I’m inspired to continue to be a part of this important work,” said Dr. Mastovska.
Since joining AOAC International in 2004, Dr. Mastovska has actively participated in the organization. In 2021, she was given the Harvey W. Wiley Award, the association’s highest scientific accolade.
She has a wealth of experience in research chemistry, having held positions with the U.S. Department of Agriculture, the University of Chemistry & Technology in Prague, and her own independent consulting firm, Excellcon International.
The most recent position Dr. Mastovska held was as a Chief Scientific Officer for Eurofins’ American Food Division.
MARCH 2023 | FOOD SAFETY AFRICA MAGAZINE FOODSAFETYAFRICA.NET 20 APPOINTMENTS UPDATE
David Tharp to culminate 30-year stint at IAFP in April
U.S – Following 30 years of service, David Tharp, the Executive Director of the International Association for Food Protection (IAFP) is set to retire on April 26, 2023.

David joined IAFP in 1993 as Director of Finance and Administration, and served as Interim Director in 1995 until he was appointed to his current role in 1997.

He successfully directed and represented IAFP at dozens of key food safety meetings worldwide, helping grow IAFP’s international status.
The association also saw a significant increase in membership, as well as Annual Meeting attendance, exhibitors, and sponsors, during David’s years as Executive Director.
USDA swears in new Food Safety Under Secretary
Frank Yiannas bows out from his role as FDA’s Deputy Commissioner, Food Policy and Response
U.S – Frank Yiannas, Deputy Commissioner, Food Policy and Response, FDA has submitted his resignation from the agency citing his concern that the decentralized structure of the foods program significantly impaired the FDA’s ability to operate as an integrated food team and protect the public.
Yiannas took the mantle as the FDA’s Deputy Commissioner for Food Response and Policy in December 2018.
U.S – The U.S. Department of Agriculture (USDA) has appointed José Emilio Esteban, Ph.D., as the organization’s new Under Secretary for Food Safety.

Dr. Esteban joined the USDA Food Safety and Inspection Service (FSIS) in 2001 and held the roles of Laboratory Director for the Western Laboratory, Scientific Advisor for laboratory services and research coordination, and Executive Associate for laboratory services.
In 2018, he was appointed Chief Scientist of FSIS. In his role, Dr. Esteban provides scientific advice to support agency policies including the disciplines of microbiology, chemistry, and pathology.
He has since served as the FDA Commissioner’s main advisor in the formulation and implementation of food safety regulations, including
His leadership, according to IAFP, was crucial during the trying years of the COVID-19 pandemic, when IAFP 2020 transitioned to a virtual event for the first time in its history and the European Symposium had to be cancelled, all without any staff turnover.
During his 30-year stint at IAFP, David played a transformative role that resulted in a name change, an increase in international conferences and workshops, a greater emphasis on student scholarships, and a solid financial foundation.
He leaves the association in a great position with a staff that is quite competent, says IAFP.
He has held positions as an Epidemic Intelligence Service Officer, Staff Epidemiologist, and Assistant Director of the Food Safety Office at the Centers for Disease Control and Prevention (CDC).
He is also the current Chair of the Codex Alimentarius Commission Committee on Food Hygiene, the committee that establishes global food hygiene standards for international trade. Moreover, he is serving as the International Association for Food Protection’s (IAFP’s) Vice President.
“Serving as the next Under Secretary of Food Safety is an opportunity to give back to a nation that has given me so much,” he said.
the historic FDA Food Safety Modernization Act (FSMA).
Food safety priorities like epidemic response, traceback inquiries, product recall operations, and supply chain innovation, have fallen under his purview.
“In December 2018, I joined the FDA with the goal of helping to modernize the food safety oversight system in the United States and protecting the American people from contaminated food.
“I wanted to build on my work of protecting consumers by elevating food safety standards and building more effective, modern, and innovative food safety approaches, something I did in the private sector for more than 30 years,” said Yiannas.
FOODSAFETYAFRICA.NET MARCH 2023 | FOOD SAFETY AFRICA MAGAZINE 21


NATIONAL BIOSAFETY AUTHORITY STEPS INTO LIMELIGHT AS KENYA OKAYS GM FOODS

Mixed reactions have followed Kenya's lifting of the 10-year ban on GMOs, bringing to light the National Biosafety Authority (NBA). The Food Safety Africa Magazine team had a seat-down with the Authority’s CEO, Dr. Roy Mugiira, in a bid to dissect their role in the industry.
By Catherine Odhiambo
The National Biosafety Authority (NBA) was established by the Biosafety Act No. 2 of 2009 to exercise general supervision and control over the transfer, handling, and use of GMOs. GMOs are products of modern biotechnology that involve the manipulation of the genetic material of organisms through genetic engineering procedures.
“GMO is either a plant, an animal or a microorganism that has new genetic composition, or that has been altered through modern biotechnology,” elaborates Dr.Mugiira.
When GMOs initially gained notoriety, customers expressed concern about their safety. Additional elements like socioeconomic status, cultural practices, and religious convictions also impacted how people perceived these new breeds. Consequently, the international community negotiated a protocol called the Cartagena Protocol on Biosafety that is anchored under the Convention on Biological Diversity, to
which Kenya is a party.
“We want to assure our consumers and particularly the Kenyan public that that which we have checked and put our seal of approval on is indeed safe,” he reiterates.
HIERARCHY OF LEADERSHIP
The Authority was founded with the goal of regulating the research and commercial use of genetically modified organisms in order to protect the environment and ensure human and animal health.
The Authority is governed by a Board of Directors comprising nine members. They include a Chairperson; representatives of four Principal Secretaries from the Ministries of Education (as the Ministry responsible for Science and Technology), The National Treasury, Ministry of Agriculture and Livestock Development, and the Ministry of Health; Two experts in the biological, environmental, and social sciences respectively, one member with financial expertise, and the Chief Executive Officer (CEO) who is an ex-
officio member.
The CEO is backed by two Directors in the Technical area, one Director in Corporate Services, another Director in Planning and Strategy, and a Director in the Legal and Cooperation area, collectively known as the "Cooperation Secretary Office.”
In addition to an operational border post in Namanga, NBA also maintains outposts at the Jomo Kenyatta International Airport (JKIA), which is overseen from the Nairobi headquarters, one in Mombasa, and the final one in Busia. These outposts are used to monitor products entering the country and guarantee compliance.
“We hope to expand but we are limited by resources. The 10-year ban didn't see quite a bit of movement in this space. That is why you have seen after the lifting of the ban, it is like we have been taken out of the freezer. Now we are out there and we hope to fall back on track quickly enough so that we can pick up our mandate as is required,” notes the NBA boss.
MARCH 2023 | FOOD SAFETY AFRICA MAGAZINE 23
REGULATOR HIGHLIGHT | National Biosafety Authority
ROBUST REGULATIONS TO MAN GMO SECTOR
Nonetheless, a number of stakeholders have expressed concern over whether the nation is prepared to end the embargo. According to Dr. Mugiira, Kenya laid down the groundwork for biotechnology way before the year 2000 when the Cartagena Protocol was signed into law by the late former President Daniel Arap Moi and later ratified in the year 2003. In 2006, Kenya published the National Biotechnology Development Policy followed by the enaction of the Biosafety act which now established the National Biosafety Authority.
In 2011, the country published three sets of regulations. One such regulation was the Contained Use Regulations published in August 2011 to guide activities involving GMOs under containment and confinement. These regulations are applied during research on GMOs while still in the laboratory, greenhouse, growth chamber, and confined field trials.
“We also published regulations for Environmental Release. If we are releasing a GM crop into the environment for cultivation, these regulations clarify the forms to be filled, any costs to be incurred, and safety evaluation procedures,” says Dr. Mugiira.
The third regulation was the Import, Export, and Transit

MARCH 2023 | FOOD SAFETY AFRICA MAGAZINE FOODSAFETYAFRICA.NET 24
Staff at the National Biosafety Authority lab in Nairobi
WE WANT TO ASSURE OUR CONSUMERS AND PARTICULARLY THE KENYAN PUBLIC THAT THAT WHICH WE HAVE CHECKED AND PUT OUR SEAL OF APPROVAL ON IS INDEED SAFE.
Dr. Roy Mugiira, CEO, National Biosafety Authority
Regulation which as the CEO points out is a hot topic of discussion currently. They give explicit protocols on importing, exporting, and transportation of GMOs and guidance on steps to undertake in case of unintended release of the items into the environment while in transit. Under the regulations, any person(s) involved in GMO import for consumption or research, GMO export to any country, and GMO transit from one country to another through Kenya is/are required to seek approval from the Authority.
Later in 2012, the Authority released the Biosafety Labeling Regulation to ensure that consumers are made aware that the food, feed, or product is genetically modified so they can make an informed decision. The regulation also facilitates product traceability to assist in the implementation of the necessary risk management strategies when necessary. The regulations aim to make it easier to accurately label products, monitor their impacts on the environment and, when necessary, human health, and put in place the necessary risk management strategies, such as pulling products off the market.
Subsequent to the release of the Biosafety Labeling Regulation, the government banned the importation and use of genetically modified crops, thanks to a publication publicized by a French scientist by the name Professor Séralini. This effectively put the NBA's regulatory system on ice.

“For 10 years, we have just been dealing with research work, except the approval of Bt cotton, which was approved in 2020 responding to the

FOODSAFETYAFRICA.NET MARCH 2023 | FOOD SAFETY AFRICA MAGAZINE 25
National Biosafety Authority buiding
need to revitalize the cotton apparel value chain. So in essence, therefore, we have been ready way before 2000.
“We have the capacity, both in our research institutions, and also our regulatory framework, which includes eight other regulatory agencies,” echoed Dr. Mugiira.
IMPORT PROTOCOLS AND SAFETY TESTS
Following the lifting of the ban, the NBA updated some facets of the Export, Import, and Transit Regulation including digitizing the application process. They also updated a platform known as KenTrade and identified a seven-step procedure to be followed by potential GM food importers. All import procedures begin with the completion of an Import Declaration Form (IDF), which details the products the importer plans to bring in, who the products are from, where they are coming from, and what components of the products are GM or non-GM. Dr. Mugiira claims that when that is indicated, it raises a flag for NBA inspection.
“So within the KenTrade platform, as KEPHIS is looking at the potential for insect pests and diseases, as KEBs is looking at moisture and aflatoxin among other things, we are looking at what GM is in that commodity,” he informs.


Subsequent to clearance from the partner organizations, NBA doesn’t conduct repeat tests owing to the large costs and a potential delay to trade. Instead, they only verify the approval of the specific gene in the commodity for use as food, feed, and processing in its country. Once verified, the findings are posted in the Biosafety Clearing House, a virtual Clearing House, where state parties to the Cartagena Protocol post all decisions. This then paves way for the release of the product
for use in the country.
“However, if the product is coming as a seed which will be required to germinate in our environment, it will be required to have been approved here for environmental release,” he points out.
GENOME EDITING UNPACKED
Last year, Kenya joined its Nigerian counterpart in establishing guidelines for the Genome Editing (GE) technology, a more recent innovation that does not involve the transfer of genetic material from one organism to another. Nonetheless, one can question the need for GE regulations given the existence of GM ones. What defines the difference between these two?
Dr. Roy clarifies that in GE, instead of bringing a gene fragment from another source, the scientists go into the organism, identify the genome of interest and edit it either by removing it or modifying it constitutively.
“Hence the crops are not classical GMOs as they
MARCH 2023 | FOOD SAFETY AFRICA MAGAZINE FOODSAFETYAFRICA.NET 26
REGULATOR HIGHLIGHT | National Biosafety Authority
FOR 10 YEARS, WE HAVE JUST BEEN DEALING WITH RESEARCH WORK, EXCEPT THE APPROVAL OF BT COTTON, WHICH WAS APPROVED IN 2020 RESPONDING TO THE NEED TO REVITALIZE THE COTTON APPAREL VALUE CHAIN.
don’t have the novel gene from another source and should not be regulated in a similar manner,” he explains.
The guidelines were developed to provide technical guidance to applicants and reviewers on which genome editing organisms and/or products are regulated under the Biosafety Act 2009 or not, as genome editing can result in either a GMO or non-GMO depending on the pathway followed in the editing process. The applicants are supposed to consult with the Authority early enough for them to assess their research and issue a verdict on the product category.
The other feature of the GE regulations is the three pathways where if the researcher ends up with GMO it becomes the NBA’s interest, if not, it becomes the interest of other regulatory agencies.
“Where there are transient stages that are GM, we regulate up to the point
KEY NUMBERS
where it has exited the GMO component. That approach resonates well with several other jurisdictions including Argentina, Nigeria, India, and Malawi.
“It is an approach that is universally agreed upon. And that has made us reasonably popular. We are now being invited to share our experiences with that approach,” says Dr. Mugiira.
NBA has so far taken three products through that process, and two others are in the pipeline. This begs the question of whether the rumored GM crops circulating in the Kenyan market are really GM…the CEO terms these crops as hybrid since they result from the crosspollination of two plant varieties to create a new plant with desired traits.
COLLABORATION WITH OTHER ENTITIES
NBA works hand in hand with several regulatory agencies as stipulated in the first schedule of the Biosafety Act. Key among them is the Kenya Plant Health Inspectorate Service (KEPHIS) which also deals in crops. Others include the Department of Public Health, Department of Veterinary Services (DVS), Kenya Bureau of Standards (KEBS), Pest Control Products Board (PCPB), National Environmental Management Authority (NEMA), Kenya Wildlife Service (KWS), and Kenya Industrial Property Institute (KIPI).

Internationally, the Authority has partnered with the African Union Development Agency NEPAD (AUDANEPAD) which manages a program called the African Biotechnology Network of Expertise (ABNE).


“This program helps African countries to develop regulatory frameworks. They’re supporting us a lot in developing our regulations around genome editing and also in the rollout of biotechnology,” he says.
They also work with an institution called the Program for Biosafety Systems, a program under the International Food Policy Research Institute (IFPRI) of the U.S., in the development of frameworks and especially in the coordination framework for the regulatory agencies. In terms of food safety assessment, they work with the Food and Agriculture Organization (FAO) of the United Nations, the World Health Organization, and the Codex Alimentarius Commission. Debunking the myths through public education
Besides the NBA’s regulatory role, the Authority is also mandated to provide public education and awareness. A lot
FOODSAFETYAFRICA.NET MARCH 2023 | FOOD SAFETY AFRICA MAGAZINE 27
THE YEAR NATIONAL BIOSAFETY WAS ESTABLISHED
2009
REGULATOR HIGHLIGHT | National Biosafety Authority
Dr. Roy underscored the need for the public to be made aware that GM farming is not the opposite of organic farming since one can grow GM crops that are also organic. Just like farmers utilize organic chemicals/fertilizers on their nonGM crops, the same can be adapted to their GM counterparts. To avoid cross-pollination with nonGM crops, the Authority recommends distancing. In the event that cross-breeding actually happens, the transgene is lost in the second generation.
“Where we want to maintain purity is at the seed production level. At the crop cultivation level, we are saying this is safe, it can go to the cultivation and we will progressively see it not appearing in the non-GM crop production system after generations of cultivation,” he explains.
REGULATORY OVERLAP AND LIMITED RESOURCES STILL A CHALLENGE
of myths and misconceptions have flooded the internet with no voice of authority to set the record straight, an issue Dr. Mugiira attributes to the 10year silence occasioned by the ban on GM foods.

“You cannot tell a story if you have nothing to tell. We are now able to tell a story because we can talk about Bt cotton, which is already with farmers. Farmers can come out themselves and even tell us their experiences generally.
“And the best way of communicating is people sharing experiences. So the 10 years, have been really quiet. And that is one of the reasons why our role in public education, public awareness, and Public Communications has been low,” he says.
In a bid to up that game, NBA is mulling on revitalizing a program launched by His Excellency, President William Ruto, when he was serving as Minister for Agriculture in 2008, known as the ‘Bio Aware program’.
“Hence, public education and awareness have long been recognized as being necessary. I have already requested financial facilitation from the government so that we can roll out a structured, coordinated public education, public engagement, public communication program,” Dr. Mugiira revealed noting that the authority currently only engages in ad hoc modes of awareness creation, an initiative that has earned him the title, ‘GMO man’.
While NBA jubilates the country’s move to open its doors to GMOs, the Authority is still left to grapple with the impacts of staying underground for over a decade. Making do with a 2010-2011 budget is no mean feat given the current economic status not only of the country but of the global community at large. This has restricted the NBA’s capacity to carry out public education and awareness and in turn, limited the potential uptake of the technology.
“Today, if you ask somebody, ‘if I made ugali from GM corn, would you partake of that meal?’ Somebody would want to run away. So it means therefore even the acceptance of the technology is low,” Dr. Mugiira says.
The Authority also has to battle with an overlap in the regulatory framework that hinders the seamless coordination among partner institutions.
“For example, within the Environmental Management Act (EMCA), there is a provision for subjecting projects of biotechnology, particularly testing of GM commodities or crops to environmental impact assessment, while we have already conducted environmental risk assessment. So it becomes like a duplication, or even an unnecessary kind of undertaking,” comments the CEO adding that there are a number of other gap areas in legal provisions that NBA intends to address with the country’s legislature.
CONTINUOUS LEARNING TO STAY ON THE RADAR OF TECHNOLOGICAL ADVANCES
To continuously keep up with the rapidly evolving scientific and technological innovations, NBA takes its staff through incessant training sessions that also encompass short courses. These training sessions are backed by partner organizations
MARCH 2023 | FOOD SAFETY AFRICA MAGAZINE FOODSAFETYAFRICA.NET 28
Mr Harry Kimutai, PS Livestock Development, Ministry of Agriculture & Dr. Roy Mugiira during the 11th Annual Biosafety Conference
like the AUDA-NEPAD. The UN has also come in handy in facilitating the Authority’s human technical capacity building. NBA has thus far held two training sessions on genome editing and the proposed regulatory framework for the Board and top policymakers in the government.
“We are also embracing IT in our operations so that we step out of the paper and file processes. Our clients who need us to clear them for GMO-free certificates can access our services virtually. This has enabled us to enhance our service delivery. So it is training, training, and some more training and also setting up the infrastructure for ICT,” informs the NBA Head.
DELICATE BALANCE BETWEEN INNOVATION AND SAFETY
As new technologies emerge, there is a risk that they could fall into the wrong hands and end up being utilized as bioweapons. Dr. Mugiira informs of the existence of a sister institution called, the ‘National Commission for Science Technology and Innovation (NACOSTI) established to specifically regulate science research and innovation. NACOSTI implements the requirements of the Biological Weapons Convention (BWC) which prohibits the development, production, acquisition, transfer, stockpiling, and use of biological and toxin weapons.
of enhancing the virulence of a disease-causing pathogen for example, for use in biological warfare, or even in hostile activities of terrorists and groups like those,” he says.
SOLDIERING ON DESPITE THE HURDLES
According to Dr.Mugiira, NBA has been able to put in place a robust science-based regulatory system that has been tested and tried over time. It is on account of this robust framework, that the former CEO, Professor Dorington Ogoyi shepherded the approval of Bt cotton amidst a very hostile environment.
“By demonstrating how Bt cotton can contribute to socioeconomic development, the Authority was able to take it through all the phases up to the doorstep of the farmer, which is a major achievement, and it has been a big test for our regulatory system,” he highlights when asked some of their achievements.
The Authority has also been able to oversee the National Performance Trials for Bt maize and was almost releasing it to farmers were it not for the obstruction by the court. Moreover, it has 32 GMO projects for contained use and 12 for confined field trials in various research facilities in the country, to date.

However, he affirms that there is a delicate balance between innovation and safety, and regulations alone cannot bridge that gap. As a result, he urges scientific professionals to self-regulate. Just as food safety is everyone’s business, responsible innovation should also be everyone’s business.
“Our role, therefore, is to ensure that this technology doesn't find itself in the wrong hands and be used for purposes
With an eye toward the future, NBA seeks to control and direct new bioscience fields including synthetic biology and the militarization of biotechnology. In the medium term, the authority has a strategic plan running through 2025 and an upto-the-task management team which Dr. Roy is confident will ensure it remains relevant in an ever-changing technology and regulatory landscape.
FOODSAFETYAFRICA.NET MARCH 2023 | FOOD SAFETY AFRICA MAGAZINE 29
YOU CANNOT TELL A STORY IF YOU HAVE NOTHING TO TELL. WE ARE NOW ABLE TO TELL A STORY BECAUSE WE CAN TALK ABOUT BT COTTON, WHICH IS ALREADY WITH FARMERS. FARMERS CAN COME OUT THEMSELVES AND EVEN TELL US THEIR EXPERIENCES GENERALLY.
Dr. Roy Mugiira, CEO, National Biosafety Authority
Foodborne pathogens in Africa: Understanding Cronobacter sakazakii
By Ifeanyi Michael Mazi, Helen Onyeaka, Nnabueze Darlington Nnaji
Cronobacter sakazakii is an emerging and opportunistic foodborne pathogen that causes severe infantile diseases, including meningitis, necrotizing enterocolitis, and septicemia. It has been reported in numerous countries around the world, including those in Africa. Although it has been isolated from food, environmental and clinical samples across Africa, the most implicated source of the C. sakazakii infection outbreaks across the globe has been the consumption of contaminated powdered infant formula (PIF).
PIF contamination can occur during the production stage for several reasons, such as poor Good Manufacturing Practices (GMP) and contaminated equipment. Owing to its high food safety risk and severity of C. sakazakii infections, especially for infants, the International Commission on Microbiological Specification for Foods in 2002 categorized Cronobacter spp. as “a serious hazard for restricted populations, life-threatening or with significant chronic sequelae over a long duration”. Neonatal infections associated with C. sakazakii have been reported to have a mortality rate as high as 80%, often leading to irreversible

MARCH 2023 | FOOD SAFETY AFRICA MAGAZINE FOODSAFETYAFRICA.NET 30
SCIENCE & RESEARCH | Foodborne Pathogens in Africa
neurological disorders for survivors
Cronobacter has many unique characteristics that contribute to its survival in harsh environments and transmission along the food chain from production to consumption. These features include the formation of biofilm; the ability to withstand critical food control steps during food production such as osmotic stress, thermal treatment, pH, detergents, starvation, disinfectants, antibiotics, and sanitizers. In addition, the organism also possesses the ability to significantly resist high temperatures (the minimum, maximum, and optimum temperatures for growth are 6, 45, and 37–43°C) and desiccation that allows it to stay up to 2–5 years in an encapsulated form in dehydrated food products (with water activity range from 0.30 to 0.83).

CRONOBACTER IMPACT GOES UNNOTICED IN AFRICA
Based on the current surveillance systems across the globe, available data shows that there is no active surveillance system for diseases caused by E. sakazakii (Cronobacter spp.), implying that most national foodborne disease surveillance centers of the world are yet to identify cases of C. sakazakii infection. Because C. sakazakii infection is rare, most sites where Cronobacter spp. disease has been reported have very low populations, and several years of monitoring/surveillance will be needed to develop a valid incidence estimate across affected populations
Generally, in less developed nations, including Africa, the impact of Cronobacter spp. often goes unnoticed.
This is corroborated by findings from Ethiopia that the overall burden of Cronobacter is grossly underreported and, to some degree, considered non-reportable compared to the significant number of other foodborne pathogens reported. Furthermore, the available data on Cronobacter spp. prevalence in follow-up formula products for babies aged 6–11 months is very scarce. This scarcity is because only a few national regulatory bodies have been able to define the Microbiological Specifications for Cronobacter spp. in these items.
Despite the increase in the number of carefully documented cases of C. sakazakii (most infections in
FOODSAFETYAFRICA.NET MARCH 2023 | FOOD SAFETY AFRICA MAGAZINE 31
CURRENTLY, THE ACTUAL BURDEN OF CRONOBACTER IN AFRICA OR WORLDWIDE, CANNOT BE DETERMINED AS NO EFFORT HAS BEEN MADE TO ESTIMATE THE FACTORS THAT MIGHT BE USED TO DETERMINE THE OVERALL BURDEN.
SCIENCE & RESEARCH | Foodborne Pathogens in Africa
infants), this number is significantly low compared to many other infectious diseases. Currently, the actual burden of Cronobacter spp., in Africa or worldwide, cannot be determined as no effort has been made to estimate the factors that might be used to determine the overall burden. The capacity of environmental, clinical, and food laboratories to successfully identify C. sakazakii infections remains a major limitation in their diagnosis. Although significant advancement has been made with the identification methodology, there is still the need for increased awareness and capacity building, as with other emerging infections.
PREVALENCE AND OCCURRENCE OF CRONOBACTER SAKAZAKII IN AFRICAN COUNTRIES
Despite global research to determine C. sakazakii prevalence, its epidemiology remains incomplete and poorly understood. Given that C. sakazakii is ubiquitous in animate (man, animals) and inanimate (soil, water, plants) environments, it is not unusual that C. sakazakii has been isolated from a variety of foods as well as animal and vegetable sources of food products, though little is known about Cronobacter existence in their various environments. The most common food implicated in Cronobacter infection globally is PIF.
The prevalence of C. sakazakii in South Africa is similar to that observed globally. In 2008, 14% of the isolates obtained from South African newborn formula milk and the processing environment tested positive for C. sakazakii. This result corroborated a previous study that showed that 18% of South African infant formula milk and other baby food products were contaminated with C. sakazakii.
In North Africa, several studies on Cronobacter

infection have been done. A 2013 study in Egypt revealed that C. sakazakii was present in the analyzed cheese, ice cream, and yoghurt samples. The isolation method employed chromogenic medium and traditional culture media. It was discovered that C. sakazakii was a significant cause of neonatal sepsis amongst preterm infants in North Africa. The identified means of bacterial infection were contaminated PIF, herbs, and water. In another research, 15% of the analyzed ground beef and beef burger samples sold in Egypt tested positive for C. sakazakii. Their results further established new epidemiological evidence that these pathogens are widespread in meat products sold in Egypt. However, this bacterium's epidemiology remains incomplete and poorly described.
In West Africa, C. sakazakii was isolated from 13% of the 185 samples analyzed to determine the occurrence of Cronobacter spp. in PIFs sold in Abidjan, Ivory Coast. The study proved to be the first published work on the contamination of PIF with C. sakazakii from Abidjan. Also, the presence of C. sakazakii isolate from pharmaceutical industries wastewaters confirmed the prevalence of C. sakazakii in Nigeria's ecosystem.
Conclusively, underreporting is attributable to the
MARCH 2023 | FOOD SAFETY AFRICA MAGAZINE FOODSAFETYAFRICA.NET 32
UNDERREPORTING IS ATTRIBUTABLE TO THE APPARENT ABSENCE OF FOODBORNE DISEASES CAUSED BY CRONOBACTER AMONGST MALNOURISHED CHILDREN WHO ARE ALSO VULNERABLE TO SEVERE INFECTIONS IN AFRICA.
apparent absence of foodborne diseases caused by Cronobacter amongst malnourished children who are also vulnerable to severe infections in Africa. This is based on the argument that in the biggest and longest running holistic surveillance carried out for invasive bacterial infections in children and infants in sub-Saharan Africa, just a few instances of invasive Cronobacter infection were reported. Of the 65,426 samples collected between 1998 and 2013, 3953 were blood and cerebrospinal fluid cultures, of which only 60 tested positive and were identified as Cronobacter species.
Worthy of note is that 39 of those 60 cultures identified as Cronobacter species were samples obtained from newborns. However, employing an automated culture system to validate the isolated microorganisms
KEY NUMBERS
carried out in Kenya by the Kenya Medical Research Institute and the Wellcome Trust Research Programme that lasted from 1998 to 2013.
TRANSMISSION ROUTES OF CRONOBACTER SAKAZAKII INTO THE FOOD CHAIN AND FOOD SAFETY CONCERNS
Clinical presentations of foodborne diseases in newborns have been associated with pathogencontaminated PIF, particularly C. sakazakii. Food contamination by C. sakazakii in PIF has been reported , and extrinsic contamination during PIF handling is thought to induce bacterial infection in infants; however, the transmission mechanism is not entirely known. Research has concentrated on food contamination by C. sakazakii during manufacture or from raw materials (i.e., intrinsic contamination).
Environmental health practices related to food preparation have been attributed to foodborne illnesses. Cronobacter infection has also been connected to unhygienic practices (extrinsic contamination source) by caregivers while preparing PIF.

further using a biochemical profile testing based on US Food & Drug Administration Bacteriological Analytical Manual, only two isolates, both from blood cultures, were confirmed to be consistent with Cronobacter. Their study took advantage of the continuous, systematic surveillance research


Cross-contamination from the caregiver to spoon to PIF can be a direct pathway for the exposure to C. sakazakii from caregiver to infants; research is limited to observational and surveys studies that do not assess actual risk. Caregivers, and bacterial reservoirs, facilitate the transmission of the pathogen to foods through direct or indirect contact. Feeding utensils, including blenders, bottles, and spoons, have been connected to Cronobacter infection when contaminated utensils are used in mixing the formula. However, the simulation of PIF handling practices and cross-contamination of ground foods for the investigation of extrinsic contamination has not been reported.
Cronobacter is most commonly transmitted to babies through contaminated PIF from opened containers; it can also be transmitted to humans when manufacturers use
FOODSAFETYAFRICA.NET MARCH 2023 | FOOD SAFETY AFRICA MAGAZINE 33
THAT TESTED POSITIVE FOR CRONOBACTER BETWEEN 1998 - 2013 60
SAMPLES
contaminated raw materials during processing or when the formula powder comes in contact with a contaminated surface. The bacteria can live in water and on surfaces in the home, including a kitchen sink or counter. Therefore, the formula powder is likely to cross-contaminate at home after its container has been opened if not properly handled.
The pathogen has been reported in wheat and rice plants during the tillering, filling, and mature stages, in water from paddy fields, soil from rice, and soil from wheat flour milling plants. Subtyping using pulsed-field gel electrophoresis revealed that some strains shared a common profile, implying the widespread presence
of Cronobacter in the environment, possible cross-contamination, and transmission routes in processing.
Cronobacter spp. has been isolated from dry milk powder, infant formulas, milk and milk-related beverages, candy and chocolate, and cereals. Additionally, research has been conducted to investigate the prevalence and distribution of C. sakazakii in a powdered milk manufacturing plant. In the spraydrying area, seven pulsed-field gel electrophoresis types were identified, which supposedly gained entrance into the plant via an improperly controlled roller shutter and a process air aperture. Also, both spray-drying towers’ textile filters for exhaust
air were identified as the pathogen internal reservoirs. Infants have also become ill due to Cronobacter bacteria that grew on breastmilk pump parts that were not adequately cleaned.
The infection was found in families whose staple foods were made from Cronobacter-contaminated wheat flour. Cronobacter transmission from human to human is unknown, but there is a possibility because other types of bacteria can be transmitted from one person to another.

MOLECULAR DIAGNOSIS OF CRONOBACTER SAKAZAKII
Apart from the conventional screening and identifying C. sakazakii, new rapid molecular assay tools have been developed over the years. Some molecular diagnostic methods of detecting Cronobacter through specific targets and recognition of the pathogen nucleic acid include the polymerase chain reaction (PCR) method; real-time PCR; multiplex PCR; repetitive element sequencebased PCR; PCR-restriction fragment length polymorphism; pulsed-field gel electrophoresis; MLST; multilocus sequence analysis (MLSA); multiplelocus variable number tandem repeat analysis, duplex PCR in mix with slender electrophoresis–laser incited fluorescence locator; molecular O-antigen typing technique; fluorescence in situ hybridization technique; and so on.
These molecular methods can detect specific target genes of the pathogen, thus fast-tracking the identification of the pathogen and tracing the sources of infection. For example, the successful phylogenetic analysis of Cronobacter isolates obtained from various environmental and food sources in South Africa was achieved using MLSA of the pathogen's strains based on two genes, 16S rRNA and rpoA. The 16S rRNA gene-based PCR identification system is a reliable tool for accurately identifying C. sakazakii isolates phylogenetically. Consequently,
MARCH 2023 | FOOD SAFETY AFRICA MAGAZINE FOODSAFETYAFRICA.NET 34
SCIENCE & RESEARCH | Foodborne Pathogens in
Africa
molecular tools can immensely aid epidemiological surveillance and investigation of Cronobacter infections and other foodborne diseases in Africa.
WAYS TO ADDRESS TRANSMISSION OF CRONOBACTER SAKAZAKII ALONG THE FOOD PRODUCTION CHAIN
The occurrence of C. sakazakii in the food chain is a serious microbiological public health challenge. Food contamination by C. sakazakii may come from non-
heated ingredients, contamination from the processing environment, or contamination post-thermal processing.
C. sakazakii transmission can be prevented during food production; therefore, using appropriate microbiological procedures to avoid post-process contamination will have a positive impact. Standardized analytical procedures are required to ensure product safety. Hazard analysis and critical control point (HACCP), GMP guidelines, and efficient environmental monitoring systems should be developed to control the risk of Cronobacter contamination in the food production supply chain, starting from raw materials to finished products.
Manufacturers have acknowledged the importance of HACCP and good hygienic practice (GHP) in controlling microorganisms. Raw material quality, sifter screens, liquid and air filters, pasteurization, storage temperatures, and metal/magnets detectors are all critical control points (CCPs) that must be addressed. In addition, the heat treatments used in food manufacturing should be effective enough to inactivate C. sakazakii.

1. Raw material selection
A variety of factors must be examined to guarantee that raw materials used in food production are microbiologically suitable: The possibility of occurrence of Cronobacter in ingredients—some are thought to be at high risk of harboring the microbe. In contrast, others are believed to be at low risk. Supplier selection is based on tight requirements (e.g., control measures that are appropriate, verification and release procedures in place, and GHPs).
Testing of raw materials to ensure the efficiency of the
FOODSAFETYAFRICA.NET MARCH 2023 | FOOD SAFETY AFRICA MAGAZINE 35
CRONOBACTER CAN BE TRANSMITTED TO HUMANS WHEN MANUFACTURERS USE CONTAMINATED RAW MATERIALS DURING PROCESSING OR WHEN THE FORMULA POWDER COMES IN CONTACT WITH A CONTAMINATED SURFACE.
SCIENCE & RESEARCH | Foodborne Pathogens in Africa
AUTHOR PROFILES

Dr Helen Onyeaka is an industrial microbiologist with over 25 years of experience. She is an Associate Professor at the University of Birmingham where she lectures and leads modules on various postgraduate and undergraduate courses in Food Microbiology, Food Safety and Chemical Engineering.
Ifeanyi Michael Mazi is a Microbiology graduate from the University of Benin and currently works with Promasidor as a Quality Assurance Officer


Nnabueze Darlington Nnaji is an Environmental Microbiologist, currently a PhD student at the Department of Microbiology, University of Nigeria. He engages his knowledge of Environmental Biology and Biotechnology in research on Bioremediation and the study of the Ecology and Biochemistry of many microbial processes.
steps is mentioned above. Because “raw” material testing alone cannot ensure adherence to the industry's high-quality standards, manufacturers using these procedures must maintain strong ties with their suppliers of “raw” material and demand strict compliance with HACCP and GMPs.
2. Heat treatment
Heat treatment may be a practical approach for removing C. sakazakii from abiotic and biotic surfaces. Elevated heat could be used to physically decontaminate important surfaces connected to the preparation and production of foods. It could be used as a processing aid to ensure product safety by using high-temperature short-time pasteurization. Temperatures of 70°C or higher were frequently required for C. sakazakii decontamination.
Other research, however, implies that the organism's osmotolerance may be more relevant in this latter area. The osmotolerant ability of these microorganisms may enhance their chance of becoming much more dominant in the environment, raising the risk and chances of food contamination during postprocessing. The use of typical pasteurization techniques has proven to inactivate C. sakazakii effectively.
3. Post-processing and packaging
The higher heat resistance of vegetative cells in dry food products is a challenge that must be addressed by evaluating prospective treatments for inactivating microbial pathogens in food. Sterilizing finished products in their dry state in sachets or cans appears to be only conceivable via irradiation. However, because of the organoleptic deterioration of the product, the method does not appear viable with the doses needed to inactivate C. sakazakii in dry conditions. Other technologies like magnetic fields and ultrahigh pressure could be viable candidates.
4. High-pressure processing
High-pressure processing (HPP) is a nonthermal method of inactivating germs by pressuring a packed food in a water-filled enclosed chamber for a brief period. The use of HPP has the advantage of preserving the freshness, flavor, color, and physical features of foods while causing minimum loss to nutritional values. HPP machines may operate at 100–1000 MPa pressure ranges. Pasteurization, previously known as a heat-based intervention, has been redefined, and HPP is now included in the definition of pasteurization as a nonthermal approach.
In an experiment to determine the sensitivity of C. sakazakii isolates to hydrostatic pressure, C. sakazakii strains were exposed to an increased hydrostatic pressure range between 200 and 600 MPa for 0 and 10 min in chicken soup, orange juice, rehydrated powdered milk, and vegetable soup. At 500 MPa, the most pressure-resistant strain of Cronobacter showed roughly three log decreases in all food. The findings demonstrated that applying increased hydrostatic pressure to biotic surfaces could help eradicate the pathogen.
CONCLUSION
The prevalence of C. sakazakii in food and environmental isolates, particularly infant foods, is a public health challenge in Africa. Still, there is evidently underreporting or underdiagnosis of this infection. The sporadic documentation of Cronobacter infection cases worldwide, particularly in Africa, means that Africa's disease surveillance systems need to do more to detect Cronobacter spp. alongside other foods, environmental, and medical disease sources.
There is also a need to standardize control measures to prevent food contamination, introduce environmental monitoring systems, and strict adherence to thermal and nonthermal food processing and packaging controls.
MARCH 2023 | FOOD SAFETY AFRICA MAGAZINE FOODSAFETYAFRICA.NET 36




FOODSAFETYAFRICA.NET MARCH 2023 | FOOD SAFETY AFRICA MAGAZINE 37 Discover the latest technologies for Africa's grains industry at the Milling & Baking Africa Expo. Meet all the international manufacturers and distributors from the World at one Show WWW.AFMASS.COM A SPECIAL PAVILLION AT: Grain Handling & Storage Solutions • Milling Equipment & Solutions • Baking Equipment, Technology & Services • Supply Chain, Automation & Control Solutions • Quality & Food Safety Solutions for Grains & Baking Industry WWW.AFMASS.COM FOOD Afmass EXPO The Future of Food in Africa JUNE 15-17, 2023 SARIT EXPO CENTRE, NAIROBI, KENYA
World Food Safety Day 2023 theme highlights the importance of food standards in protecting public health
WORLD FOOD SAFETY DAY
By Catherine Odhiambo
The Food and Agriculture Organization (FAO) together with the World Health Organization (WHO) have unveiled “Food standards save lives” as the theme for the 2023 World Food Safety day. The theme is aimed at recognizing the importance of food standards across the world in keeping consumers safe, and in underpinning equitable trade in food.
Now in its fifth year, the International Food Safety Day is aimed at encouraging everyone to adopt and accept food safety standards across the food supply chain, from the producer to the consumer FAO and WHO were given special responsibility by the United Nations
(UN) to promote food safety and its significance globally. In turn, the two bodies resolved that every year, June 7, will be observed as World Food Safety Day. A resolution designating June 7 each year as “celebrating the myriad benefits of safe food” was approved by the UN General Assembly on December 20, 2018. Almost two months later, the World Health Assembly adopted a resolution designating June 7 of each year as World Food Safety Day.

In 2022, the event was held under the theme, “Safer food, better health”.

Corinna Hawkes, Director of the FAO Food Systems and Food Safety Division, invites participation in World Food Safety Day this year in a dedicated video message.
“FAO supports countries to transform agri-food systems so that they benefit people and the planet,” she says in the video, noting that policymakers, practitioners, and investors should reorient their activities to increase the sustainable production and consumption of safe foods.
Prior to the 7 June observance, an event guide has been released in all six official UN languages to provide an overview of the theme, facts and numbers, event ideas, and key messages that might be used to promote awareness and motivate action on World Food Safety Day.
The purpose of International Food Safety Day is to encourage everyone to adopt and accept food safety
MARCH 2023 | FOOD SAFETY AFRICA MAGAZINE FOODSAFETYAFRICA.NET 38
OPINION | World Food Safety Day 2023
standards across the food supply chain, from the producer to the consumer. This will aid in lowering the almost wholly preventable incidence of foodborne illness.
“We tend to think about food safety only when we get sick, but we should think more often because foodborne diseases are entirely preventable. Let me tell you that behind the scenes, countless people work to make sure that our food production follows established food safety practices,” says Dr. Maria Neira, Assistant Director General, Universal Health Coverage/Healthier Populations at WHO, in a promotional video.
Some of the basic tenets FAO and WHO will be advocating during the 2023 World Food Safety Day include; ‘There is no food security without food safety’, ‘Food safety has a direct impact on health’, ‘Science is key to sound food safety management’, ‘Food safety impacts positively on economies and livelihoods’, ‘Food standards protect consumers’, ‘Food standards help producers’, ‘Science underpins food standards’, and ‘Everyone is a risk manager.’
FOOD STANDARDS THE BEDROCK OF TRUST
WHO estimates that around 420,000 people around the world die every year after consuming contaminated food, while children under 5 years of age carry 40% of the foodborne disease burden, with 125, 000 deaths every year. Moreover, contaminated food hinders the growth of many middleand lower-income economies, which suffer losses of about US$110 billion due to incapacity, serious illnesses, or even early death.
It is on this background that FAO and WHO came together to establish the Joint FAO/WHO Food Standards Programme and the Codex Alimentarius Commission in 1963. The Commission was established to steer the development of international food standards, guidelines, and codes of practice to protect the health of consumers and ensure fair practices
in the food trade. The Commission also promotes the coordination of all food standards work undertaken by international governmental and nongovernmental organizations.
Codex food safety standards, guidelines, and recommendations are recognized as the reference for food safety in the World Trade Organization Sanitary and Phytosanitary (WTO SPS) Agreement. Codex standards are also taken into account as international standards in the implementation of the WTO Technical Barriers to Trade (TBT) agreement.
Food standards help to guarantee the safety and quality of food. They offer guidance to farmers and food processors on how to handle food in a hygienic manner. They specify the maximum levels of additives, contaminants, residues of pesticides, and veterinary drugs that can safely be consumed by all. Standards also outline how food should be measured, packaged, and transported safely. Consumers can determine whether the product is good for them thanks to the implementation of standards for things like nutrition and allergen labeling.
“Food safety standards protect everyone’s life. They are key to ensuring safety and quality. That’s why the WHO together with FAO leads global expert groups and provides scientific advice to develop international food safety standards to protect consumers’ health,” says Dr. Maria Neira.
“Safe food allows the uptake of nutrients and promotes human development. Nobody should die from eating food. These are preventable things,”
SIX DECADES ON; CODEX STANDARDS STILL AT THE HEART OF FOOD SAFETY
Through an open and inclusive process, Codex technical committees strive to create texts for standards, recommendations, and codes of practice. The texts are created
with input from 243 observer organizations, including business and consumer associations, and are supported by scientific guidance from international expert panels led by FAO and WHO. The "food code" expands every year as new requirements are added and current standards are revised when new information becomes available.
A total of 236 standards, 84 guidelines, 56 codes of practice, 126 maximum levels for contaminants in food, and more than 10,000 quantitative standards covering maximum levels for food additives and maximum residue limits for pesticides and veterinary drugs in food have been created by Codex to date.
“In 2023, as Codex turns 60, we celebrate food standards for defining the path to safe food for everyone everywhere,” voices the Commission.

To this end, World Food Safety Day aims to transform food systems to deliver better health sustainably and prevent foodborne diseases. This day also provides an opportunity to strengthen efforts to ensure that
the food we eat is safe and reduce the burden of foodborne illnesses globally.
Even as we prepare to mark this year’s edition, FAO and WHO continue to echo that “Food Safety is everyone’s business”. “No matter who you are or what you do, you play an important role in making sure food is safe to eat,” they say.
FOODSAFETYAFRICA.NET MARCH 2023 | FOOD SAFETY AFRICA MAGAZINE 39
WHO report indicates
By Catherine Odhiambo
From ancient of days, sodium chloride, popularly known as salt, has been used as a food flavour enhancer, turning otherwise insipid and unpalatable foods into opulent treats. Nonetheless, the European Food Safety Authority (EFSA) estimates that over 75% of the salt we consume comes from the foods we purchase, leading to excessive salt consumption.
The World Health Organization (WHO) has also noted with concern that the global average daily salt intake is more than double its recommended levels, placing the world off-course to meeting its 2025 goal of a 30% reduction in sodium intake. As a result, it has urged Member States to swiftly implement rules to reduce sodium intake and lessen the negative effects of excessive salt intake. The WHO has also called on food manufacturers to set ambitious salt

reduction targets for their products.
“In 2013 all 194 WHO Member States committed to reducing the population’s sodium intake by 30% by the year 2025. Since then, progress has been slow and only a few countries have been able to reduce sodium intake. But then again, no one has been able to achieve the target. As such, it is being considered to extend the target to 2030,” said Dr. Francesco Branca, MD, Ph.D., Director, Department of Nutrition for Health and Development (NHD) at WHO.
MAXIMUM ALLOWABLE LIMITS
The Organization recommends fewer than 5 grams (one teaspoon) of salt per day, whereas the average salt intake worldwide is estimated to be 10.8 grams per day. Table salt (sodium chloride) is the primary source of sodium, however, it can also be found in other condiments like
MARCH 2023 | FOOD SAFETY AFRICA MAGAZINE FOODSAFETYAFRICA.NET 40
Salt, an all-time source of flavour proves to be a rising tingle of death,
FORMULATION | Salt
sodium glutamate. Salt in the diet can come from processed foods, either because they are particularly high in salt (such as ready meals, processed meats like bacon, ham and salami, cheese, salty snack foods, and instant noodles, among others) or because they are consumed frequently in large amounts (such as bread and processed cereal products). Salt is also added to food during cooking (bouillon and stock cubes) or at the table (soy sauce, fish sauce, and table salt).
Even while sodium is a necessary nutrient, says WHO, excessive salt intake is the key risk factor for food and nutrition-related mortality. It is becoming more and more clear that eating a lot of sodium increases the risk of developing other illnesses like obesity, osteoporosis, kidney disease, and stomach cancer.
IMPLEMENTATION STATUS OF MEMBER STATES
An estimated 7 million lives could be saved worldwide by the implementation of highly costeffective salt reduction strategies by 2030, which is an important component of action to achieve the Sustainable Development Goal
KEY NUMBERS
5 Grams
AVERAGE DAILY INTAKE OF SALT RECOMMENDED BY WHO
(SDG) target of reducing deaths from noncommunicable diseases. Yet, only nine nations (Brazil, Chile, Czech Republic, Lithuania, Malaysia, Mexico, Saudi Arabia, Spain, and Uruguay) now have a complete set of recommended policies to lower sodium intake.


According to the WHO report, 73% of WHO Member States do not fully implement these policies. A further 22% of Member States (43) have put at least one required policy or measure into effect. While 29% (56) of the remaining Member States have made a policy commitment to reducing sodium intake, 33% of them (64) have adopted at least one voluntary policy and other measures to do so.
Proportion of Member States implementing mandatory and/or voluntary sodium reduction policies and other measures

“Unhealthy diets are a leading cause of death and disease globally, and excessive sodium intake is one of the main culprits. This report shows that most countries are yet to adopt any mandatory sodium reduction policies, leaving their people at risk of heart attack, stroke, and other health problems.
“WHO calls on all countries to implement the ‘Best Buys’ for sodium reduction, and on manufacturers to implement the WHO benchmarks for sodium content in food,” said Dr. Tedros Adhanom Ghebreyesus, WHO Director-General.
MULTIFACETED APPROACH NEEDED
Adopting mandatory regulations and the four salt-related WHO “best buy” measures, which make a significant contribution to the prevention of noncommunicable illnesses, are part of a comprehensive approach to sodium reduction. These include reformulating foods to contain less salt, setting targets for the amount of sodium in foods and meals, and establishing public food procurement policies to limit salt or sodium-rich foods in public institutions such as hospitals, schools, workplaces, and nursing homes. It also involves front-of-package labeling that helps consumers select products lower in sodium and behaviour change communication, and mass media campaigns to reduce salt/sodium consumption.
Reformulation is more prevalent in the higher-income groups and is more frequently used in the WHO Eastern Mediterranean and European regions. The first reformulation regulations were put in place in the 1980s by various Member States, which set maximum allowable limits for the amount of sodium in products like bread, tomato sauces, and peanut butter. By 2013, when the WHO Global Action Plan for the Prevention and Control of Noncommunicable Diseases was established and sodium
FOODSAFETYAFRICA.NET MARCH 2023 | FOOD SAFETY AFRICA MAGAZINE 41
in the food supply was advised to be reduced, over half of the Member States with mandatory or optional sodium reduction reformulation policies had implemented this.

In 2022, WHO developed benchmarks for sodium content in 18 food categories and called on food operators to implement them globally. It is once again encouraging these countries to utilize the policies to set sodium content targets. Mandatory salt reduction programs are thought to be more effective because they attain wider coverage, protect against commercial interests, and give food manufacturers an equal playing field.
AFRICAN COUNTRIES FALL BEHIND THE RIMES
Meanwhile, as other regions make progress in the national commitments and policy implementation to cut sodium intake, the African region seems to be taking the tail end with no Member State having reached score 4 as shown in the Sodium Country Score Cards. To document progress made thus far, WHO developed a Sodium Country Score Card for Member States based on the type and
number of sodium reduction policies they have in place.
Nevertheless, there is still hope for the continent as Seychelles recorded a score of 3 thanks to the implementation of a public food procurement and service policy that mandates standards for sodium content and having implemented mandatory declaration of sodium on pre-packaged food.
In 2008, Seychelles approved a National School Nutrition Policy that establishes requirements for school meals as well as guidelines for the serving of food at fundraisers, in tuckshops, and other events. The recommended salt intake for schoolaged children is 210 mg/day for children in creche, 360 mg/day for children in primary school, and 480 mg/day for children in secondary school. The guidelines for school meals are that these should not contribute more than 30% of that amount.
No meals with low nutritional value should be offered or sold, according to the rules for tuckshops, fundraisers, and other events. In 2018, revisions were made to the tuckshop regulations to incorporate a traffic
light system for easier categorization of foods and beverages with low, moderate, and high nutritional values.
The national government formulated an implementation guideline, along with a sample lease agreement for school tuckshops and a monitoring tool. Every school was required to have local school nutrition action groups, made up of a teacher, student, parent, tuckshop owner, dining staff member, school nurse, dental therapist, and district representative, who were responsible for monitoring. There are, however, very few schools where this group has been established and is still active, says the report.
Using the monitoring technology, central and local authorities also keep track of nutrition in schools at least once a year and communicate their findings to the management team of each relevant school.
Moreover, four other Member States have put mandatory measures into effect but do not entirely meet the criteria for scoring 3. Although not requiring a salt disclosure on every pre-packaged food item, Cabo Verde, Mauritius, and South Africa all have required regulations with an underlying nutrient profile model that includes sodium. Algeria, however, has no other obligatory requirements other than the mandatory salt declaration on pre-packaged food.
Ten Member States only have voluntary programs to reduce sodium and maintain a score of two. Countries like Algeria, Cabo Verde, Comoros, Eritrea, Gambia, Guinea, Madagascar, Mauritania, and South Africa have launched media campaigns to create awareness whereas Senegal has set voluntary reformulation targets.
In South Africa, the advocacy group Salt Watch was founded in 2014, funded, in part, by the National Department of Health through the Heart and Stroke Foundation South Africa. In addition to identifying items high in salt and the need to minimize sodium added during cooking and to food at the table, it was mandated to
MARCH 2023 | FOOD SAFETY AFRICA MAGAZINE FOODSAFETYAFRICA.NET 42
Salt
FORMULATION |
undertake a mass media campaign to raise public awareness about the relationship between high sodium intake, blood pressure, and cardiovascular disease.
The behavior change-based campaign featured a wellknown South African medical professional and media figure. Following rigorous testing, the campaign ran for six months, airing on average 44 times on television and 131 times on radio each month. Activities to promote the campaign included the distribution of lower-sodium recipes, informational and educational materials, the Salt Watch website, and other resources to different venues and healthcare providers. The campaign also increased print and social media awareness and uptake. An assessment of the campaign revealed a considerable shift in behavior toward reducing salt consumption.
With only a national policy commitment to reduce sodium intake and no additional voluntary or required actions, 26 Member States in the Region (55%) remain in score 1. As a result, the African Region now has the greatest proportion of Member States that are only committed to national policy.

The status of the other ten member states; Angola, Botswana, Cameroon, Democratic Republic of the Congo, Congo, Equatorial Guinea, Guinea-Bissau, Liberia, Malawi, and South Sudan has either not been addressed or is unknown.
URGENT ACTION NEEDED
With the feedback at hand, WHO has pledged to support Member States in their efforts to adopt, implement and monitor mandatory sodium reduction legislation. Moreover, according to the Organization, if all nations speed up the adoption of policies to assure the application
of best practices and at least two required interventions, sodium intake could be significantly decreased by 2030.
“This important report demonstrates that countries must work urgently to implement ambitious, mandatory, government-led sodium reduction policies to meet the global target of reducing salt consumption by 2025.
“There are proven measures that governments can implement and important innovations, such as low sodium salts. The world needs action, and now, or many more people will experience disabling or deadly—but preventable—heart attacks and strokes,” said Dr. Tom Frieden, President and CEO of Resolve to Save Lives, a notfor-profit organization working with countries to prevent 100 million deaths from cardiovascular disease over 30 years.
FOODSAFETYAFRICA.NET MARCH 2023 | FOOD SAFETY AFRICA MAGAZINE 43
WITH ONLY A NATIONAL POLICY COMMITMENT TO REDUCE SODIUM INTAKE AND NO ADDITIONAL VOLUNTARY OR REQUIRED ACTIONS, 26 MEMBER STATES IN THE REGION (55%) REMAIN IN SCORE 1.
Sodium reduction policies and other measures implemented in the African Region
South Africa’s draft labeling regulations envisioned to encourage better food choices
By Catherine Odhiambo
When a consumer walks into a supermarket shelf and picks a product, the first thing that stands out is the labeling on the product. These labels act as truth serums, revealing to the consumers what exactly they’re purchasing. However, as consumers become more health conscious, manufacturers
are also coming up with more innovative ways of designing misleading labels to convince consumers to sign up for highly processed and unhealthy food products.
To this end, South Africa’s Department of Health has recently published a massive 238-page document referred to as the Regulations Relating to the Labelling and Advertising of Foodstuffs that seeks to make significant

MARCH 2023 | FOOD SAFETY AFRICA MAGAZINE FOODSAFETYAFRICA.NET 44
REGULATORY | South Africa's Labeling Regulations
changes to the way food items are labeled on store shelves in South Africa. The proposed changes not only reinforce many of the regulations that are already in place in South Africa for product packaging, such as ingredient lists and sell-by dates, but they also bring in a number of updates for more contemporary changes in food advertising.
REGULATIONS TO DETER HYPED UP SALES LANGUAGE
This includes dropping fashionable labels for foods like “smart food” or “intelligent food,” among others. The regulations recommend banning the use of phrases like “wholesome,” “nutritious,” “nutraceutical,” or “super food” and similar terms on labels as part of a reorganization of nomenclature modifications. The new regulations also forbid the use of any additional phrases, emblems, or visuals that have a similar connotation and suggest that the meal is superior in any way, including the brand and trade name.
Other claims on the package that can be deceptive are another area where the government intends to crack down. The terms “grain-fed,” “grass-fed,” “Karoo lamb,” “natural lamb,” “country reared,” “free range,” “pure,” etc. may still be used on products, but they must be connected to a specific protocol that has been approved or registered with the Department of Agriculture or is subject to the Agricultural Product Standards Act.
Foods that are not subject to the Agricultural Product Standards Act may still use claims that they are “fresh,” “natural,” “nature’s,” “pure,” “traditional,” “original,” “authentic,” “real,” “genuine,” “home-made,” “farmhouse,” “hand-made,” “selected,” “premium,” “finest,” “quality,” or “best,” but these claims must be supported by the ingredients.
Other labels that are prohibited are those that come from organizations, celebrities, or any kind of medical professional. Claims that a product offers a nutritionally balanced diet are likewise off-limits. Foods or drinks with brand names that contain a health claim may continue to use the brand name for six months after the promulgation of these regulations, only if the brand name was registered before 1 May 1995 (if after, they cannot).
MANDATORY BLACK-AND-WHITE WARNINGLABEL SYSTEM
The rules are also extremely futuristic, preparing for a new generation of products that may replace beef in the future. As a result, the regulations state that the word “meat” may not be used in the name or description of any product if the percentage of meat present is less than 25%.
For pre-packaged foods that are heavy in sugar, salt, and unhealthy fats, which are known to raise the risk of obesity, type 2 diabetes, and several malignancies, the draft regulations mandate a mandatory black-and-white warning-label system. Despite the consumers’ desire to
make healthier food choices, most lack the know-how of decoding these labels, thus rendering them useless. As such, writing these labels in a simpler language would be more beneficial.
Additionally, the necessary warning labels will apply to foods and beverages that include artificial (nonnutritive) sweeteners, which have recently been found to be detrimental to gut flora and, over time, to raise the risk of obesity, type 2 diabetes, and cardiovascular illnesses.
Due to South Africa’s rising rates of obesity and noncommunicable diseases like diabetes and cardiovascular disease, nutritionists and epidemiologists have been eagerly awaiting the new regulations.
WAY, INCLUDING THE BRAND AND TRADE NAME.
Nearly 80% of pre-packaged foods on South African supermarket shelves are highly processed or ultraprocessed, containing excessive amounts of added sugars, salt, unhealthy fats, and chemical additives that make them irresistibly tasty, as shown by a study conducted in the Western Cape. Since these foods make up large proportions of many South Africans’ diets, they are also “fueling new levels of death and disease with almost no regulation to stand in their way.”
When the draft is adopted, pre-packaged foods that contain more than 10g of total sugar per 100g or more than 5g per 100ml, more than 4g of saturated fats per 100g or more than 3g per 100ml, or more than 400mg of sodium per 100g or more than 100mg per 100ml must display a front-of-pack warning label.
FRONT-OF-PACK LABELING
A warning label is necessary for any level of artificial sweetener in foods and beverages. For instance, sweetened carbonated beverages that contain both sugar and artificial
FOODSAFETYAFRICA.NET MARCH 2023 | FOOD SAFETY AFRICA MAGAZINE 45
THE NEW REGULATIONS ALSO FORBID THE USE OF ANY ADDITIONAL PHRASES, EMBLEMS, OR VISUALS THAT HAVE A SIMILAR CONNOTATION AND SUGGEST THAT THE MEAL IS SUPERIOR IN ANY
sweeteners will need to have warnings for each of those components. The front-of-pack-labeling (FOPL) must be prominently displayed and, insofar as possible, integrated into the package. The FOPL cannot be fully or partially covered by any other element, according to the department. Such logos must be visible on the front of the packaging of the relevant foodstuffs, and they must take up to 25% of the front surface.
Since 2004, the World Health Organization (WHO) has urged nations to adopt front-of-pack labeling laws as a means of enhancing consumers’ ability to make healthy food choices. Ingredients must be listed on labels “in descending order of mass present in the end product”, i.e.

“in household terminology or measurements” must all be included in nutritional information presented under the heading “(TYPICAL) NUTRITIONAL INFORMATION/ FACTS” (the word “typical” is optional). Nutritional data must be provided for each individual serving as well as per 100g or 100 ml of the product.
HEALTHY LIVING ALLIANCE BACKS NEW REGULATIONS
The Department of Health’s decision to publish the draft regulation, which comes shortly after a protest march in Johannesburg that the Healthy Living Alliance (HEALA) organized in November 2022 to demand that the government mandate warning labels for unhealthy foods, has been commended by the Alliance.
“This step taken by the government is long overdue given the thousands of South African citizens who have succumbed to the effects of non-communicable diseases such as diabetes, and heart disease, due in part to a poorly regulated food environment.
“Following global trends, South Africans are consuming increasing amounts of ultra-processed foods, leading to adverse health complications and poor health outcomes for a lot of South Africans, including children,” HEALA said.
HEALA has been pushing for the government to implement front-of-pack warning labels “to help people make better choices and live healthier lives” along with a broad range of academics, dietitians, and public-health specialists.
Several nations, including Singapore (1998), Thailand (2007), Chile (authorized in 2012, implemented in 2016), Ecuador (2013), Indonesia (2014), Mexico (2016), and, most recently, Colombia, have mandated warning labels, “traffic-light” labeling, or “healthy choice” labeling systems (2022).
ingredients must be listed from highest to lowest relative weights. In the case of “mechanically recovered”, separated or deboned meat (typically used in processed meats), if the percentage of meat included in a product is less than 25%, the name and description of the end product may not contain the word “meat”.
All food labels must include a table containing nutritional information or facts, with the exception of those made “by a small producer or street vendor” (small is not defined), or if the product is one of a select group that includes things like baking powder, beer, coffee, honey, teas and infusions without additional ingredients, vinegar, and “spray and cook type products.”
A single serving’s weight or volume, the number of single servings per container, and a description of a single serving
Legislation permitting member states (and a select few others, such as Norway and Switzerland) to create voluntary front-of-pack recommendations showing “guideline daily quantities” or traffic-light forms of portraying nutrients in foods was approved by the European Union in 2011.
According to HEALA, even though they may not be aware of it, consumers worldwide including in South Africa have difficulty understanding traditional nutrition labels (such as the “nutrition information panel” listing the energy, protein, carbohydrate, fat, and fiber composition of foods).
Recent focus-group studies (in 2020 and 2022) have shown that warning labels, particularly those in black and white like those incorporated in the new regulation, are easily understood by South Africans and are highly effective in influencing their food purchasing intentions away from unhealthy foods and beverages.
The Department has opened the floor for public feedback till 30 April 2023.
MARCH 2023 | FOOD SAFETY AFRICA MAGAZINE FOODSAFETYAFRICA.NET 46
| South Africa's Labeling
REGULATORY
Regulations
Practical guidance on risk-based approaches to assess and manage fitfor-purpose water in the dairy industry
By Catherine Odhiambo
The Global Commission on the Economics of Water has warned that the world is facing an imminent water crisis, with demand expected to outstrip the supply of fresh water by 40% by the end of this decade. Water is utilized for a variety of purposes, and the dairy industry is one such industry that uses a significant amount of first-use drinking water for cleaning, disinfection, and production processes.
With the world currently advocating for sustainable food systems, the Food and Agriculture Organization of the United Nations (FAO) and the World Health Organization (WHO) have recently published a report that guides the dairy industry on food-safe sourcing, use, and reuse of fitfor-purpose water.
“The dairy industry offers significant possibilities for utilizing potential sources of reusable water,” says the report.

In 2020, the 43rd session of the Codex Alimentarius Commission (CAC) approved the new work entitled “Development of Guidelines for the Safe Use and Reuse of Water in Food Production” proposed by the 51st session of the Codex Committee on Food Hygiene. The Joint FAO/ WHO Expert Meeting on Microbiological Risk Assessment (JEMRA) was tasked with supporting this work by offering expert guidance on the safe use and reuse of water in the dairy industry.
To provide clear and useful information on risk-based ways to assess and manage fit-for-purpose water source, use, and reuse in the dairy sector, JEMRA organized an
FOODSAFETYAFRICA.NET MARCH 2023 | FOOD SAFETY AFRICA MAGAZINE 47
INDUSTRY FOCUS | Water Re-use in the Dairy Industry
INDUSTRY FOCUS | Water Re-use in the Dairy Industry
Overview of fit-for-purpose considerations for different water use purposes and types of water reuse
DIRECT FOOD CONTACT
Fit-forpurposes as sourced
Fit-for-purpose until undue level of significant hazards are found; needs reconditioning to reuse
Fit-forpurpose if no significant hazard present either as recovered or after reconditioning
Fit-forpurpose if no significant hazard present either as recovered or after reconditioning
Fit-for-purpose if no significant hazard present either as recovered or after reconditioning
Fit-for-purpose if no significant hazard present either as recovered or after reconditioning
procedure such as purification or antimicrobial treatment, is necessary prior to application. In order to guarantee the final product’s food safety, the report emphasizes that every water reuse scenario, such as the combination of reusable water source and reuse water application, including specifics like recovery, reconditioning, storage, and distribution, must be carefully examined.
FACTORS TO CONSIDER WHEN CREATING A WATER REUSE SCENARIO
When creating and running a water reuse scenario, dairy companies should refer to the pertinent regulatory requirements. Water reuse and control should take into account particular conditions, such as the microbial status of the water source and the microbiological requirements associated with the reuse water application, to ensure the food safety of the finished product.
UNINTENDED FOOD CONTACT
Fit-forpurposes as sourced
NOT FOR FOOD CONTACT
Fit-for-purpose as recovered if no significant hazards are present, or food contact is avoided
Fit-forpurpose as recovered if no significant hazards are present, or food contact is avoided
Fit-for-purpose as recovered if no significant hazards are present, or food contact is avoided
Fit-forpurposes as sourced
Fit-for-purposes as sourced
online meeting from June 14 to July 2, 2021. The study provides a summary of prospective sources of reusable water in dairy processing and considerations for its application.
WATER TYPES FOR REUSE
Examples of water types that could potentially be sourced for reuse include water that was part of a dairy product or has come into a dairy operation in the form of drinking water and is recirculated until it
Fit-forpurposes as sourced
Fit-forpurposes as sourced
is no longer suitable as drinking water. Water that has been used for cleaning purposes in the food processing operation or other parts of a facility and water that is part of a dairy operation’s effluent can also be reused.
Applications of reuse water can broadly be categorized as not-forfood-contact or for-food-contact. Whether reuse water is intended for or not intended for contact with food will determine if a reconditioning
It is also important to take into account the ability to control potential hazards and the microbiological efficacy of the reuse water generation system, which is related to the combination of the technologies, equipment, and infrastructure employed for water recovery, reconditioning, and storage. In addition, it should consider the need to consistently control the reuse water generation system and the application of the reuse water produced in the day-to-day operation, not forgetting the role of microbial testing for validation and verification in designing and managing reuse water generation and use, as well as the ability to apply appropriate testing approaches.
ESTABLISHING APPROPRIATE CONTROLS
Additionally, when assessing potential microbiological hazards and establishing appropriate controls for reuse water generation and use, FAO suggests taking into account
MARCH 2023 | FOOD SAFETY AFRICA MAGAZINE FOODSAFETYAFRICA.NET 48
PURPOSES FIRST - USE WATER RECIRCULATES WATER RECLAIMED WATER RECYCLED WATER e.g Potable sources Closed Loop Recovered from a food material Recovered from a process step FOOD INGREDIENT Fit-for-
purposes as sourced No likely application
the microbial hazards present in the possible reusable water sources, as well as hazards associated with other parts of the operation that could contaminate a reuse water supply after it has been produced

Manufacturers should take into account the nutrients present in a reuse water supply after recovery and reconditioning that may foster the growth of spoilage organisms or microbiological hazards and whether reuse water that has been recycled or recirculated multiple times in a specific process operation is leading to or has resulted in biofilm formation. They should also ponder whether any particular measure for the preservation of the product or control of microbial growth is required over the set shelf-life of the reuse water supply. Moreover, FAO accentuates the need to have available a backup fit-for-purpose water supply, such as a drinking water source, that can be used in case the reuse water generation system is not under control or has failed.
The report draws parallels between the management of water supply generation and controls for food safety, such as the significance of adopting a risk- and evidence-based strategy. The validation of recovery, purification, or antimicrobial treatment requirements for each water reuse scenario is also crucial. The reuse water generation process should be monitored daily while in operation, along with regular verification of its microbiological status. If necessary, the report advises using third-party contractors.
In conclusion, the report advises food business owners to adjust each water reuse scenario to the unique circumstances of their particular food operation. They should take into account the goal of water reuse, readily accessible sources of reusable water, the reuse water generation system, and underlying processes, storage and shelf-life of reuse water supplies, the approach to managing reuse water generation and application, and
the skills and expertise available to manage day-to-day the implemented water reuse scenario at the facility.
KNOWLEDGE GAPS STILL AT LARGE
The research also reveals knowledge gaps and needed improvements in capacities and capabilities, particularly in low-resource settings. “While the interest in water reuse is increasing in dairy operations and other food sectors in several parts of the world, the practical deployment of water reuse scenarios in full-scale operations is lagging.
“The awareness of stakeholders (i.e. from food industries and their service providers, government authorities, academia, and consumers) on the urgency and benefits of increasing water reuse all along the food supply chain needs first to be raised,” reads the report in part.
ability to conduct an appropriate risk assessment and hazard analysis for a particular water reuse scenario.
There exists a lack of ability to assess the effectiveness of individual or combined technologies for the recovery and reconditioning of reusable water supplies and for mitigating relevant hazards to acceptable levels for the intended purposes, including an appreciation of risk-contributing factors such as biofilm formation and availability of nutrients.
In addition, there is a lack of knowhow in the validation of recovery, reconditioning, shelf-life/storage, and application technologies as well as the operational management during full-scale operation, including how to monitor and verify key operational aspects to ensure overall control.
The report also discovered a gap in the deployment of suitable or alternative technologies for recovering and reconditioning water in dairy operations that have limited resources, capabilities, and technical infrastructure.
Such gaps include among others, the understanding of the types and levels of microbial, physical, and chemical hazards potentially present in reusable water sources within dairy operations, as well as the
FAO and WHO are encouraging international stakeholders to share information, knowledge, expertise, and other resources, particularly when it comes to establishing efficient systems for generating reuse water and implementing reuse water supplies in small to large dairy production and processing facilities.
FOODSAFETYAFRICA.NET MARCH 2023 | FOOD SAFETY AFRICA MAGAZINE 49
WHETHER REUSE WATER IS INTENDED FOR OR NOT INTENDED FOR CONTACT WITH FOOD WILL DETERMINE IF A RECONDITIONING PROCEDURE IS NECESSARY PRIOR TO APPLICATION.

AOAC Africa launches Laboratory Performance Benchmarking Program to enhance testing capability
A collaborative approach to driving and delivering effective and sustained improvement in analytical laboratories
By AOAC Africa
The role of routine laboratory testing services is critical for the development of the region's agro-based economies. In addition to laboratory testing, the inspection and certification of agricultural commodities and agro-based products must comply with regulations.
The basic food regulatory standards in the region are based on the Codex Alimentarius Guidelines (unless otherwise specified). Adherence to these standards is critical for acceptance and pricing by recipients, so testing laboratories must provide proof of conformity to these regulations and do so under an acceptable standard.
Testing laboratories should adhere to the universally accepted ISO/IEC 17025 standard and be accredited. Test methods should at a minimum be validated and, ideally, be included in the scope of the accreditation. The laboratories must be periodically assessed for performance under ISO/IEC 17025 to ensure that they generate universally comparable results. This is one of the greatest needs in the region: that methods must yield results to a comparable minimum performance. To achieve this, it is important to train analytical scientists in the appropriate methods.
To build capacity in the laboratory testing service sector in the region,
the AOAC Africa Section launched the Laboratory Performance Benchmarking Program (LPBP), which aims to determine the baseline testing capability of laboratories in the region, identify the root causes of poor performance, and close the gaps through direct mentorship of participating laboratories. A diagrammatic representation of the AOAC Africa Section LPBP is shown in Figure 1.

THE PROGRAM
The Laboratory Performance Benchmarking Program (LPBP) started by determining the baseline testing capability of laboratories in the region, with the main objective of identifying key analytes and their analytical methods that require special attention. The key analytes were defined based on their importance for public health and trade and included aflatoxins (in peanut slurry and maize), mycotoxins (in peanut
FOODSAFETYAFRICA.NET MARCH 2023 | FOOD SAFETY AFRICA MAGAZINE 51
Figure 1. Five stages of the AOAC Africa Section Laboratory Performance Benchmarking Process
slurry and maize), and vitamins and minerals (iron, zinc, calcium, potassium, and phosphorus) in
fortified maize. To establish a baseline performance expectation based
on regulatory requirements and product standards, the Standard Method Performance Requirements (SMPRs) were set for each of the analytes in various matrices. The SMPRs evaluated specific method performance criteria, which included accuracy, precision, limit of detection and operational range.
The protocol invited participating laboratories to use their existing methods of analysis, as employed in routine testing. The method used, whether in-house, from literature, or from standard methods (such as AOAC, ISO, CEN, etc.), was to be reported. Results should have been reported in triplicate, with 3 independent samples analysed on 3 different days.
The results submitted by the participating laboratories were compared to the target performance and reported as "pass" or "fail" based on their actual performance. In the first round of the AOAC Africa Laboratory Performance Benchmarking Program, 38 food testing laboratories from 8 African countries took part.
Peanut slurry (levels 1 and 2) and maize samples were distributed to all registered laboratories in October 2021. The aflatoxin results for peanut slurry (in triplicate) were obtained from 84% of registered laboratories. The standard analytical method performance requirements for the quantification of total aflatoxin and aflatoxin B1 in peanut slurry was defined as shown below in Table 1.
The overall performance for the accuracy of quantification of aflatoxins in peanut slurry is shown in Figure 2. The results showed that 64.7% of the participating labs achieved the target performance for AFB1, while 54.5%, 63.6% and 53.8% of labs achieved the target performance for, AFB2, AFG1 and AFG2, respectively.
Figure 3 illustrates a general need for method improvement to achieve acceptable method performance in terms of accuracy. This study

MARCH 2023 | FOOD SAFETY AFRICA MAGAZINE FOODSAFETYAFRICA.NET 52
AFLATOXINS B1, B2, G1, G2 TOTAL AFLATOXIN Operational Range (ppb) 0.1–50 ppb 1–100 ppb Recovery (%REC) 70 – 125% 70 – 125% Repeatability (%RSD) <25% <25% Measurement Uncertainty 44% 44%
SCIENCE & RESEARCH | AOAC AFRICA
Table 2. Aflatoxin concentration levels in the AOAC LPBP Peanut slurry samples.
AFLATOXIN CONCENTRATION (PPB) LEVEL 1 CONCENTRATION (PPB) LEVEL 2 B1 29 3.53 B2 9.4 0.69 G1 13.5 2.71 G2 6.7 2.43
Figure 2. Shows the overall accuracy performance of the participating laboratories when compared to the target method performance for the quantification of aflatoxins B1, B2, G1, and G2 in peanut slurry
Table 1. Standard (target) analytical method performance requirements for the quantification of total aflatoxin and aflatoxins B1, B2, G1 and G2 in the AOAC LPBP peanut slurry samples.
shows that between 30% and 45% of the laboratories have poorly performing methods as depicted by the blue bars.
MYCOTOXINS IN MAIZE
Naturally incurred standard reference samples were given to the participating laboratories and analysed according to the agreed protocol (three times in duplicate on three separate days) in order to generate the method performance data. The Standard Method Performance Requirement for the detection and quantification of 6 different mycotoxins, [AFB1); Total Aflatoxins, Ochratoxin A (OTA), Deoxynivalenol (DON), Zearalenone (ZEA) and Fumonisins (FBs)] are shown in Table 2.
Of the participating laboratories, 85% submitted results for Total Aflatoxin, 55.5% submitted results for AFB1 and 22.2% submitted results for other mycotoxins (OTA, ZEA, DON and FBs). The levels of participation are shown in Figure 2.


While most of the participating laboratories submitted results for the Aflatoxins, only a relatively low number of labs submitted results for the other mycotoxins. This implies that most of the participating laboratories lack the capacity to quantify other important mycotoxins.
The Assigned Values for each mycotoxin in the maize sample i.e., AFB1, Total Aflatoxins, OTA, ZEA, DON, and FBs were 29.4 ppb, 35.6 ppb, 4.1 ppb, 58 ppb, 144 ppb and 5,621 ppb, respectively. The overall
FOODSAFETYAFRICA.NET MARCH 2023 | FOOD SAFETY AFRICA MAGAZINE 53
AFB1 TOTAL AFLA OTA DON ZEA FBS Operational Range (ppb) 0.1–50 1–100 0.1–50 50–5000 5-300 10–5000 Recovery* 70 -125% 70 – 125% 70 – 125% 80 – 120% 80-120% 80 – 120% Repeatability <25% <25% <25% <25% <25% <25% Measurement Uncertainty 44% 44% 44% 44% 44% 44%w
Table 2. Standard method performance requirement for AFB1, Total Afla, OTA, DON, ZEA and FBs based on regulatory standard.
Figure 3. Shows the percentage of the participating laboratories that submitted results for Total Aflatoxins, AFB1 and other mycotoxins (OTA, ZEA, DON and FBs).
Figure 4. Shows the percentage of laboratories achieving the target accuracy performance. Results reported as PASS achieved the target performance while those reported FAIL did not meet the target accuracy performance.
performance of the laboratories for the quantification of mycotoxins in maize is shown in Figure 4.
The results shown in Figure 3 show that there are significant deficits in the reliability of the results for mycotoxins in maize. While there was overall better performance for Total Aflatoxins and AFB1, 70% and 50% of the results respectively, were not reliable i.e., failed to achieve the target standard method performance. The overall performance for the other mycotoxins were considerably worse. The results show that only very few of the participating laboratories achieved the target performance for OTA, ZEA, DON and FBs in maize. These results show that of the laboratories that participated in the AOAC Africa Section LPBP, only a relatively small number of laboratories had the capacity and capability to quantify other mycotoxins (other than Aflatoxins), and of these laboratories, only very few achieved the target method performance.
For the trade of safe foods within the Africa Continental Free Trade Area (AfCFTA), it is imperative that laboratories in our region expand their current capacity and capability for multi-mycotoxins quantification as well as identify the root cause(s) of poor performance and use these findings to improve their analytical method performance.
NUTRITIONAL ANALYSIS OF MAIZE
Standard reference samples of ground yellow maize fortified with vitamins A (retinol), B1 (thiamine), B2 (riboflavin), B3 (niacin) and B6 (pyridoxal 5′-phosphate), and minerals (iron, zinc, calcium, potassium, and phosphorus) were sent to the participating laboratories where they were analysed according to the agreed protocol (as previously described). The assigned values for ash, moisture and protein content were 2.837 g/100g, 4.00 g/100g and 13.34 g/100g, respectively. The assigned values for vitamins A, B1, B2, B3 and B6 were 0.788 mg/100g, 0.387 mg/100g, 0.91 mg/100g, 6.778 mg/100g and 0.96 mg/100g, respectively. The assigned values for iron, zinc, calcium, potassium, and phosphorus were 8.39 mg/100g, 5.85 mg/100g, 305 mg/100g, 663 mg/100g and 525 mg/100g, respectively. The Standard Method Performance Requirements for the detection and quantification of the above-mentioned target nutritional analytes are shown in Tables 3, 4, and 5.
The results submitted by the participating laboratories show that 78%, 86% and 100% of the labs testing for protein, moisture, and ash content respectively, achieved the target analytical method performance. This is shown below in Figure 5. These results show that 22% and 14% of the labs did not meet the target performance for protein and moisture content respectively.
The results submitted for the minerals showed that many of the participating laboratories did not achieve the target performance. The results show that 65%, 63%, 50%, 82% and 78% achieved the target performance for iron, zinc, calcium, potassium, and phosphorus respectively.
Table 3. Shows the Standard (or target) analytical method performance requirements for protein, ash and moisture content in fortified maize flour.
Table 4. Shows the Standard (or target) analytical method performance requirements for iron, zinc, calcium, potassium, and phosphorus content in fortified maize flour.
mg/100g ≤ 5%
Table 5. Shows the Standard (or target) analytical method performance requirements for vitamins A, B1, B2, B3 and B6 content in fortified maize flour.
MARCH 2023 | FOOD SAFETY AFRICA MAGAZINE FOODSAFETYAFRICA.NET 54 PARAMETER TARGET PERFORMANCE Analytical Range 1 – 250 mg/100g Limit of Quantitation (LOQ) 1.0 mg/100g Recovery 90 – 110% Repeatability (RSDr) 1 – 10
≤10%>10
≤
(RSDR) 1
≤10%>10
PARAMETER TARGET PERFORMANCE Analytical Range 1
Recovery
PARAMETER TARGET PERFORMANCE Recovery 90
110%
(RSDr) Ash 3.4% Repeatability (RSDr) Moisture 3.2%
mg/100g
mg/100g
5% Reproducibility
– 10 mg/100g
mg/100g ≤ 5%
– 250 mg/100g Limit of Quantitation (LOQ) 1.0 mg/100g
90 – 110% Repeatability (RSDr) 1 – 10 mg/100g ≤10%>10 mg/100g ≤ 5% Reproducibility (RSDR) 1 – 10 mg/100g ≤10%>10
–
Repeatability
Repeatability (RSDr) Protein 2.7%
SCIENCE & RESEARCH | AOAC AFRICA
This is shown in Figure 6. The percentage of participating laboratories achieving the target
performance for vitamins in fortified maize is shown in Figure 7. The results show that none of the labs achieved

the target performance for vitamin A, while 58% achieved the target performance for vitamins B1 and B2, 76% achieved the target performance for B3 and only 40% achieved the target performance for B6.

PRIMARY CAUSES OF UNSATISFACTORY PERFORMANCE
The primary objective of the AOAC Africa Section LPBP is to evaluate the performance of laboratories in the region, determine the root causes of poor performance and work directly with laboratories to implement corrective actions that will result in the overall continuous improvement of the performance of laboratories in our region. Following the performance evaluation phase, laboratories were required to identify and report the causes of unsatisfactory performance.
In order to support laboratories in identifying the root cause of poor performance, training on problemsolving and root cause analysis was provided to laboratories. The training provided a structured and systematic approach to problem-solving and continuous improvement.
The primary causes of the unsatisfactory performance of this cohort of participating laboratories were grouped into three categories; pre-analysis, analyses phase, and post analysis phase.
In the pre-analyses phase, poor sample handling, unsuitable storage, and poor physical infrastructure were some of the highlighted causes of poor performance. Poor homogenization prior to subsampling, inefficient extraction, non-calibration of instrument nots, use of unsuitable analytical methods, and competence of Laboratory Analysts (not adequately trained) influenced the unsatisfactory performance during the analyses phase. Meanwhile, in the post-analysis phase, transcription errors in reporting in wrong/unusual units, and the absence of an adequate report quality verification process
FOODSAFETYAFRICA.NET MARCH 2023 | FOOD SAFETY AFRICA MAGAZINE 55
Figure 6. Shows the overall performance of the participating laboratories that analysed iron, zinc, calcium, potassium, and phosphorus in fortified maize standard reference samples. Laboratories achieving the target performance is classified as PASS while those not achieving the target performance is classified as FAIL
Figure 5. Shows the overall performance of the participating laboratories that analysed ash, moisture and protein content in fortified maize standard reference samples. Laboratories achieving the target performance is classified as PASS while those not achieving the target performance is classified as FAIL.
before results are reported were named as culprits.
RESULTS UNDERSCORE NEED OF MEASURING OVERALL PERFORMANCE OF ANALYTICAL METHODS

The outcome of the AOAC International Africa Section Laboratory Performance Benchmarking Program, which focuses on the real-time measurement of the key performance characteristics of some agreed tests of certain food matrices, has highlighted the importance of measuring the overall performance of analytical methods and their application, as well as the reliability of the results produced by many of our laboratories, whether ISO 17025 accredited or not.
Based on the findings presented in this white paper, AOAC believes that adopting (and expanding) such a program for laboratories in our region will help them to identify deviations in their overall performance and their root causes, thereby allowing them to carry out focused
improvement activities to achieve the target performance as required for regulatory conformity compliance. It can also serve to inform users of analytical services of the analytical method-specific performance rating (a qualitative measure) of the
laboratory services provider, thereby building confidence in test results, reducing the likelihood of resultsrelated disputes and the associated financial and reputational losses that can occur as a result of such disputes.
In order to support the agricultural-based economic growth plan for Africa and to facilitate the trade of safe and quality foods under AfCFTA (encompassing ARSO’s one standard, one test, one certificate accepted everywhere principle), the AOAC Africa LPBP provides an excellent independent platform to raise the standards and performance in laboratories as well as giving confidence to analytical services users.
We are therefore inviting all food testing labs in the region to participate in the AOAC Africa Section LPBP. It is important to note that the LPBP is not a proficiency test scheme, nor does it replace the ISO/IEC 17025 requirement for participation in an ISO/IEC 17043 accredited P-Test scheme. However, laboratories can use participation in the LPBP to demonstrate active participation in multi-lab testing programs as required by the ISO/IEC 17025 standard.

MARCH 2023 | FOOD SAFETY AFRICA MAGAZINE FOODSAFETYAFRICA.NET 56
SCIENCE & RESEARCH | AOAC AFRICA
Figure 7. Shows the overall performance of the participating laboratories that analysed vitamins A, B1, B2, B3 and B6 in fortified maize standard reference samples. Laboratories achieving the target performance is classified as PASS while those not achieving the target performance is classified as FAIL.
Please complete the following details
Telephone: Website:
Email:
What best describes your main business activity (e.g. hospital, banking, consultant, packaging supplier, NGO)
What best describes your job:
Chairman, CEO, Director General Management
Sales/Marketing
Purchasing/Supply chain
QA/R&D Process Management
Others (specify)
NOTE: An invoice will be generated once we receive this form

Would you like us to have a feature on your company? Yes



Applicant’s Signature & Stamp:
Date:
Subscribe Name: Company: P.O. Box:
Town: Physical
Country:
Post code:
Location:
FW AFRICA PO BOX 1874 - 00621 Village Market, Nairobi, KENYA Tel: +254 20 8155022 | Cell: +254 725 343932 Email: info@fwafrica.net Corporate Website: www.fwafrica.net Keep up to date with the food safety & quality sector
KENYA REST OF AFRICA REST OF WORLD 1 year KSh 5,900 USD 120.00 USD 200.00 2 years KSh 11,500 USD 220.00 USD 380.00
Subscription form
DETAILS OF SUBSCRIPTION * Food Safety Africa is published 4 times a year. Prices inclusive of airmail where applicable
Get your own personal copies
Number of copies Number of years
GROW YOUR BUSINESS FASTER, MORE SUSTAINABLY
WHY ADVERTISE IN FOOD SAFETY AFRICA MAGAZINE


• Reach the agriculture, food, retail and HORECA and beyond using one publication and website



• The first and only magazine focused on food safety, quality and compliance management in Africa




• The first magazine of its kind in the region available in a digital format, providing our advertisers with a worldwide audience
• The best read and visited food safety, quality and compliance management Africa.

ADVERTISE IN AFRICA'S NO.1 FOOD SAFETY, QUALITY & COMPLIANCE MAGAZINE
AVAILABLE IN PRINT & FOR FREE ONLINE AT: WWW.FOODSAFETYAFRICA.NET




















































 The Africa CEO & Leadership Forum
The Africa CEO & Leadership Forum